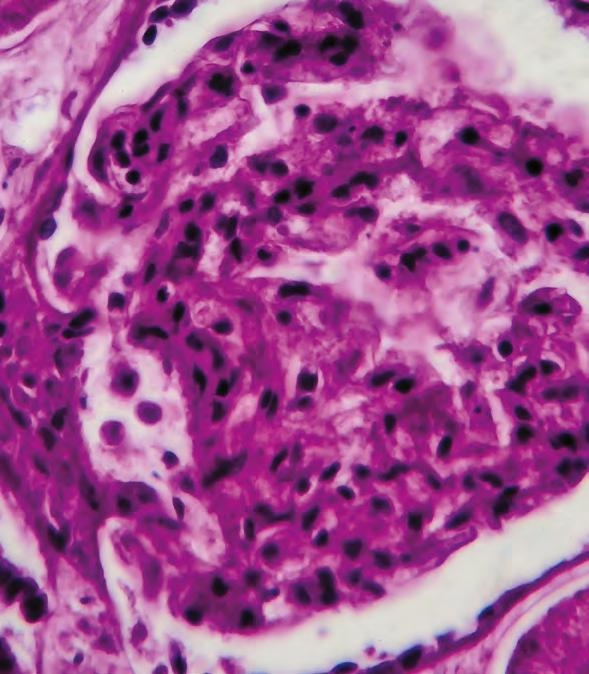

ENCICLOPEDIA
ODONTOLÓGICA
Técnicas de desplazamiento gingival para una buena toma de impresión
BOLETÍN
La fresadora de quinta generación: Ceramill Matron de Amann Girrbach promete serious fun
PUNTO DE VISTA
Lupus y cavidad oral















CALIDAD Y DIRECCIÓN
Teleodontología: un método para optimizar la atención dental

SONRIENDO AL FUTURO
Tratamiento ortodóncico en paciente adulto tratado con extracciones de primeros molares permanentes. Reporte de caso










BOLETÍN
Mucho cuidado con los equipos de rayos x intraorales portátiles. ¿Está justi cada esta advertencia?
ESTUDIO
¿Bloque óseo autólogo o xenogénico para ensanchar la cresta alveolar?









dentistaypaciente.com
No. 189/Mayo 2024 Latindex 17964 $50.00 MX ISSN: 1455-020X Revista ������������


























"PREPÁRATE" ¡NO FALTES!



Del 1 al 5 de mayo se realizará la 78 Expo AMIC, la exposición dental más grande del mundo de habla hispana y el Congreso Nacional e Internacional de la Facultad de Odontología UNAM-AMIC Los Angeles Dental Meeting 2024, en el WTC de la Ciudad de México. Tendremos, como siempre, nuestro stand, en el cual podremos atender a todos nuestros amigos, colaboradores y nuevos suscriptores. Esperamos saludarlos en el evento.
Hace un año, para ser exactos, el día 5 de mayo, la OMS declaró el fin a nivel mundial de la pandemia por COVID-19. Algo esperado con mucha ansiedad; sin embargo, hay que recordar que el virus llegó para quedarse, para formar parte de nuestra vida diaria, así como lo han hecho otros virus con anterioridad.
Debemos seguir observando las medidas de protección como el uso de cubrebocas y el ventilar adecuadamente los espacios cerrados. De hecho, el virus ha seguido mutando e incluso ha habido otras olas de contagio, pero menos dañina debido a las vacunas. Ahora ya podemos comprarlas en algunas farmacias.
Queremos felicitar a los maestros y a todas las mamás que festejan su día en este mes, aunque como siempre decimos: para las mamás cada día del año es su día.
¡Síganse cuidando!
Dentista y Paciente 2 Editorial
Mayo 2024
Mtro. Carlos Adolfo Espinosa García Especialidad en Odontología Legal y Forense Maestría en Odontología




























10 | ENCICLOPEDIA ODONTOLÓGICA

























Técnicas de desplazamiento gingival para una buena toma de impresión



















































22 | BOLETÍN









































La fresadora de quinta generación: Ceramill Matron de Amann Girrbach promete serious fun
































6 Contenido Dentista y Paciente

Editorial Renascence S.A. de C.V.



Directora editorial
Patricia López Guerra patricia.lopez@dentistaypaciente.com



Jaime Francisco Martínez Aceves† jmartinez@dentistaypaciente.com

Directora Editorial

Mariangel Martínez López mmartinez@dentistaypaciente.com




Director de Arte y Diseño Jesús Salas Pérez jesasez@dentistaypaciente.com
Coordinador Editorial




















Lupus y cavidad oral







28 | PUNTO DE VISTA







Marco A. Vergara Salgado marversa@dentistaypaciente.com
Ejecutivos Comerciales y de Negocios





Carlos Martínez García, Gabriela Dolorez Ocadiz, Edson Aarón Hernández
Producción y Circulación
Edson Aarón Hernández
Fotografía e Ilustraciones
Editorial Renascence Suscripciones
Edson Aarón Hernández


34 | CALIDAD Y DIRECCIÓN
Teleodontología: un método para optimizar la atención dental


Preprensa e Impresión
Offset Impresión Creativa S.A de C.V. Distribución
Comercializadora GBN S.A. de C.V.
Calzada de Tlalpan #572, desp. C-302, col. Moderna
Contabilidad y Administración
L. C. y E. F. Renato Muñoz
director científico
Dr. Carlos Espinosa García Especialista en Odontología Legal y Forense consejo editorial




Dr. Francisco Javier Diez de Bonilla Calderón Catedrático de la F.O de la UNAM




Dr. Francisco Magaña Moheno Centro de Especialidades Odontológicas
Javier Portilla Robertson
Exdirector de la Facultad de Odontología de la UNAM
Especialista en Patología Bucal
Contenido 189. Mayo 2����2�� 7
Dentista y Paciente
C.D.E.O. Arturo Alvarado Rossano† Profesor y Especialista en Ortodoncia y Ortopedia Craneofacial en la Facultad de Odontología. UNAM. Asesor Académico y Coordinador de Difusión de la AMOCOAC.
C.D. Manuel García Luna y González Rubio
Dra. Ana Gabriela Carrillo Varguez Coordinadora de la especialidad en endodoncia UABC Tijuana. Coordinadora de Investigación y Posgrado F.O. UABC
M.C. Ernestina Santillana Marín Subdirectora de CISALUD UABC
William James Maloney, D.D.S.
Clinical Associate Professor New York University
universidad anÁhuac méXico norte
C.D. Carlos Robles Bonilla
Coordinador de la Licenciatura de Cirujano Dentista
C.D. Sergio Antonio Ojeda León
Profesor Titular de Odontopediatría de la Licenciatura de Cirujano Dentista
C.D. Bernardo Grobeisen Weingersz
Profesor Titular de Clínica Integral de la Licenciatura de Cirujano Dentista
C.D. Norma Ibañez Mancera.
Profesora Titular de Patología Bucal de la Licenciatura de Cirujano Dentista
Dirección del Derecho de Autor certificado de reserva al uso exclusivo no. 04-2008022718312200-102 con fecha 27 de Marzo del 2008. Gobernación de la H. Comisión Calificadora de Publicaciones y Revistas Ilustradas, certificado de licitud de contenido 5328, certificado de licitud de título 7411, franqueo pagado, publicación mensual permiso no. PP09-02106, SEPOMEX.
Las opiniones expresadas en los artículos y en los anuncios publicados no significan de ninguna manera juicios, criterios, ideas o cualquier otro concepto por parte de la editorial; reflejan únicamente las ideas y pensamientos de sus autores. Los artículos, entrevistas, resúmenes, publirreportajes, fotografías y cualquier otro material son exclusivos de la editorial, y no se autoriza la reproducción total o parcial por ningún medio sin previa autorización del editor. Para cualquier asunto relacionado con suscripción, distribución, comercialización, anuncios, contenido u otro propósito, favor de dirigirse a la editorial. Impreso en MV IMPRESIONES, SA DE CV.
Dentista y Paciente® Publicación mensual correspondiente al mes de MAYO DE 2024. editada por Editorial Renascence S.A. de C.V., Rancho Jigüingo 29, Prado Coapa, Ciudad de México, 14350. tel. 56846632, fax 56793656. Distribuida en locales cerrados, depósitos dentales, universidades, congresos y exposiciones. Editora responsable: Mariangel Martínez López. Fotoarte de portada: Editorial Renascence.
DISTRIBUCIÓN CERTIFICADA POR EL PADRÓN
NACIONAL DE MEDIOS IMPRESOS DE LA DIRECCIÓN GENERAL DE MEDIOS IMPRESOS DE LA SECRETARÍA DE GOBERNACIÓN
NO. 007-136. WWW.GOBERNACION.GOB.MX
8 Contenido

52 | SONRIENDO AL FUTURO



Tratamiento ortodóncico en paciente adulto tratado con extracciones de primeros molares permanentes. Reporte de caso



































62 | ESTUDIO


















¿Bloque óseo autólogo o xenogénico para ensanchar la cresta alveolar?

















































































58 | BOLETÍN













Mucho cuidado con los equipos de rayos X intraorales portátiles
















¿Está justi������a��a ��sta a��������t������ia��















Contenido 189. Mayo 2����2�� 9
Enciclopedia odontológica

10
Dentista y Paciente
Fotoarte: Editorial Renascence | Fotografía: AdobeStock

Técnicas de desplazamiento gingival para una buena toma de impresión




Carlos Alberto Fernández Aguado Cuenca. Residente de segundo año de Rehabilitación Oral del Centro Educativo Multidisciplinario en Rehabilitación Oral, CEMRO, Tarímbaro Michoacán.
Víctor Francisco Madrigal Franco. Rehabilitador Oral, Uruapan, Michoacán. Benjamín Alberto Lázaro Castillo. Maestría en Ciencias Odontológicas. Profesor e investigador del Centro Educativo Multidisciplinario en Rehabilitación Oral, CEMRO, Tarímbaro, Michoacán.
La impresión dental está buscando constantemente mejorar la precisión y la eficiencia en la reproducción de las terminaciones. La técnica de impresión con doble hilo retractor y cofia de acrílico, que proporciona una matriz estable para la impresión, surge como una alternativa.
Objetivo: generar protocolos que brinden la precisión de la impresión en la zona de terminación, empleando las siliconas por adición, bajo las técnicas con doble hilo retractor y de cofia de acrílico. Metodología: bajo la revisión literaria se generaron ambos protocolos de impresión, teniendo en cuenta la fidelidad, el tiempo requerido para la toma de la misma y diversos factores que garanticen una comunicación adecuada con el laboratorio dental, respecto a la zona de terminación. Conclusiones: ambas técnicas son satisfactorias, dependerá de la habilidad del operador para decidir con cuál trabajar y que sus tiempos se reduzcan sin sacrificar el margen de la preparación, evitando así una microfiltración futura que pueda comprometer la restauración y el órgano dental.
Palabras clave: impresión dental, retracción gingival, doble hilo retractor, cofia de acrílico.
189. Mayo 2024 11 Técnicas de desplazamiento gingival para una buena toma de impresión
Las impresiones se toman para registrar la información y condiciones exactas de los tejidos circundantes a la prótesis fija, pero el éxito depende de factores asociados al clínico, materiales de impresión seleccionados y condiciones del paciente, siendo la impresión la parte más relevante. La adaptación marginal e interna de las coronas totales son importantes, su mala adaptación puede producir irritación gingival, disolución del cemento y subsecuente fracaso del tratamiento.1 Se decía que los ingredientes tóxicos de los materiales eran la razón principal de los problemas pulpares posrestauraciones, actualmente se conoce que la disolución de productos bacterianos a la pulpa es la causa principal de dichos problemas asociados a la microfiltración marginal.2
No debería existir esta discrepancia marginal entre el diente y la restauración, ya que acumula mayor placa bacteriana y aumenta la microfiltración, lo que promueven la disolución del agente cementante, ocasionando caries dental secundaria, enfermedad periodontal y una posible necrosis pulpar.3 Una buena adaptación marginal disminuye la probabilidad de caries, enfermedad periodontal y fracaso de la restauración.4
La discrepancia marginal no debe ser mayor a 120 μm, en la discrepancia interna no hay aún un consenso entre los autores, pero la gran
mayoría coincide en que debe ser uniforme, pudiendo oscilar en un rango de 50 a 350 μm.5 La aleación cromo cobalto (Co-Cr) se puede utilizar con los sistemas convencionales de colado o mediante sistemas digitalizados CAD/CAM5.6 Vojdani y colabs. analizaron sistemas de CAD/CAM, para evaluar la adaptación de cofias de Co-Cr con línea de terminación de hombro de 90°. Reportaron un promedio de adaptación marginal para fresado de bloques blandos de 195±1 μm y de adaptación interna de 143±1 μm; en cambio para fresado de bloques duros se obtuvo un promedio de adaptación marginal de 104±3 μm y de adaptación interna de 77±1 μm. Para la obtención de cofias metálicas se puede utilizar la técnica CPC, que consiste en encerar un patrón de cera perdida colada por centrifugación (CPC) y técnica de fresado de bloque blando (SMB) en CAD/CAM.7 El propósito de analizar este tema es proponer un protocolo actualizado de la toma de impresión con cofia y con doble hilo.
Espacio biológico
Gargiulo y colabs. en 1961, lo refirieron como la dimensión del espacio que los tejidos ocupan sobre el hueso alveolar.8 La medida de la profundidad histológica del surco es solamente de 0.5 mm; sin embargo, la profundidad clínica del surco puede ir desde 1 a 3 mm.9 Por esta razón es
La técnica de doble hilo tiene una gran ventaja y es que al penetrar 2 hilos en el surco se genera un espacio mayor, logrando con esto que, a la hora de ser inyectado el material ligero, entre una cantidad mayor de material, con lo que se conseguirá que el silicón logre entrar al surco.
Dentista y Paciente 12 Enciclopedia odontológica


muy importante hacer un adecuado sondeo en el surco gingival y determinar hasta dónde se encuentra la cresta ósea y poder así establecer una estética más predecible.10,11 La dimensión total del tejido gingival supracrestal (TGS) es de 2.04 mm (2.73 mm si se tiene en cuenta el surco gingival).10 El surco gingival debe quedar libre de cuerpos extraños para evitar reacciones inflamatorias que inician la enfermedad periodontal; sin embargo, se acepta una profundidad de 0.5 a 1 mm.12
Toma de impresión con cofias
Hay diferentes procedimientos para la confección de impresiones protésicas definitivas. Una de ellas es la cofia de acrílico. Cannistraci en 1965 describió un procedimiento en el cual se utilizan los provisionales acrílicos como una especie de cofias: luego de abocardarlos internamente, se da espacio al material de impresión y sobre este una cucharilla de
impresión o prefabricada, sobre las cofias.13
En cuanto al método mecánico, se dejó de usar por desplazar los tejidos blandos, separando la encía al registrar la preparación.14 Aunque era un daño menor sobre el tejido gingival, este cicatriza mucho más rápido al compararlo con el daño ocasionado por el hilo impregnado con epinefrina o con la utilización de electrocirugía.15
Ofrece beneficios significativos. Estas cofias proporcionan una estructura estable que mantiene la integridad de los tejidos mientras tomamos la impresión con material de elastómero, lo que es esencial para garantizar un buen registro en la toma de impresión.16 Brinda comodidad al paciente durante el proceso de los registros de impresión.14 Las cofias unidas entre sí permiten impresiones múltiples y se confeccionan siguiendo los contornos, también son excelentes medios
Dentista y Paciente 14 Enciclopedia odontológica
Figura 1. Hilos retractores de la numeración 000 y 00, con el agente hemostático.
de separación gingival sin dañar el periodonto.17
Toma de impresión con hilo retractor
Al preparar el tallado coronal y enseguida realizar la retracción gingival, clínicamente se observan signos de hemorragia ligera. Para disminuirla o evitarla, el hilo se debe humedecer o lubricar, además se puede conseguir un mayor ensanchamiento del surco; de lo contrario puede llegar a lesionar los tejidos gingivales. Para humedecer el hilo retractor se llegó a emplear alumbre, cloruro de aluminio y cloruro de zinc; este último debe manipularse adecuadamente ya que puede
causar daños.18 Estos materiales contienen sales de aluminio y causan una isquemia transitoria haciendo que el tejido gingival se contraiga, esto ayuda a controlar la exudación del fluido gingival. El cloruro de aluminio es un material idóneo, dado que causa una lesión tisular mínima.19
La técnica de doble hilo tiene una gran ventaja y es que al penetrar 2 hilos en el surco se genera un espacio mayor, logrando con esto que, a la hora de ser inyectado el material ligero, entre una gran cantidad mayor de material, con lo que se conseguirá que el silicón logre entrar al surco.11 La técnica de doble hilo obtuvo mejores resultados numéricos comparada

189. Mayo 2024 15
impresión
Técnicas de desplazamiento gingival para una buena toma de
Figura 2. Hilo retractor 00, previamente embebido en el hemostático.

con la técnica de cofia, aun así, la diferencia no es estadísticamente significativa.20
Metodología
Toma de impresión con doble hilo
Luego de aplicar enjuague bucal y anestesiar la zona, colocar el hilo retractor UltrapakMR 000 (Figura 1),

antes sumergir en ViscostatMR (Figura 2), puede ser por mesial o distal. Probar la cucharilla total de impresión, una vez seleccionado el tamaño ideal, tomar 2 porciones de masilla elite P&PMR (base y catalizador) se trabajan 1:1, da un tiempo de hasta 2 minutos de trabajo fuera de boca. Mezclar hasta formar una masa de color uniforme, colocar en la cucharilla y llevar a boca, realizar movimientos para generar espacio para el material ligero (dichos movimientos deben de ser en sentido horizontal, hacia los lados y adelante). Ya endurecido el material, retirar de boca y liberar las retenciones existentes con el fanally cut de VamasaMR. Colocar el segundo hilo retractor UltrapakMR 00, antes sumergir en ViscostatMR, posteriormente retirar el excedente hemostático del hilo con una gasa y llevar a boca. Colocar iniciando en interproximal y la terminación dejarla sobre la cara vestibular del diente para que su remoción sea sencilla,
Dentista y Paciente 16 Enciclopedia odontológica
Figura 3. Ambos hilos ya colocados.
Figura 4. Ligero desgaste en la parte interna de la cofia.
Técnicas de desplazamiento gingival para una buena toma de impresión



189. Mayo 2024 17
Figura 5. Cucharilla tipo Rimlock y adhesivo universal.
Figura 6. Colocación de material ligero en la cofia.



dejar 10 minutos para que cumpla su función de retracción y hemostasia (Figura 3).
Enjuagar la zona donde se colocaron los hilos y secar, retirar el segundo hilo y colocar el material ligero usando la punta mezcladora intraoral directamente sobre el espacio generado por ambos hilos, entre la encía y el diente, después llevar el material ligero sobre la masilla y llevar a boca 3 minutos. Al retirar la cucharilla lavar y desinfectar, dejar pasar 30 minutos para que el polivinilsiloxano
pase su fase de contracción. Se sugiere correr las impresiones con yeso NicStoneMR.
Toma de impresión con cofia
Utilizar otro provisional de acrílico (sin importar la oclusión), únicamente generar un poco más de espacio en la parte interna para crear un espacio para el material de impresión ligero (Figura 4).
Colocar un adhesivo especial (Figura 5), para que el polivinilsiloxano de consistencia ligera se adhiera a la cofia de acrílico, y esta cofia queda atrapada en la cucharilla con el material de consistencia pesada o masilla. También realizar retenciones externas con un fresón delgado. Colocar el material ligero ZhermackMR en la parte interna de la cofia y llevar directamente sobre las preparaciones dentales (Figura 6). Colocar la cucharilla con el material pesado de ZhermackMR y esperar 3 minutos en lo que endurece. Una vez que se extrajo la cucharilla de boca se procede a lavar y desinfectar (Figura 7). Después, colocar el yeso sobre la impresión para obtener el modelo necesario para el estudio.





Dentista y Paciente 18 Enciclopedia odontológica
Figura 7. Toma de impresión final.








Técnicas de desplazamiento gingival para una buena toma de impresión

























































































































































 189. Mayo 2����2��
189. Mayo 2����2��
Conclusiones
Para la odontología, la toma de impresiones es un proceso crítico con el fin de lograr la precisión necesaria en la fabricación de prótesis dentales. La utilización de técnicas como la toma de impresiones con doble hilo retractor y la toma con cofia de acrílico representa avances significativos en este campo.
Ambas técnicas buscan superar desafíos comunes en la toma de impresiones, en prótesis fija la integridad del margen es de suma importancia, así como una impresión que copie perfectamente el
terminado de la preparación, ya que de esto depende la adaptabilidad de la prótesis que permita la supervivencia de la restauración y el mantenimiento de la salud periodontal en la boca del paciente.
La toma de impresión con doble hilo retractor contribuye a una forma de impresión más precisa y, en última instancia, a un ajuste óptimo de la restauración final.
El clínico deberá conocer las ventajas y desventajas de cada material y técnicas, y su entrenamiento para elegir el material de impresión en cada caso.
Referencias
1. Quante, K., Ludwigb, K., & Kern, M. (2008). Marginal and internal fi t of metal-ceramic crowns fabricated with a new laser melting technology. Dent Mater, 1311-1315.
2. Macchi, R. (2007). Materiales Dentales (Vol. 1a Edición). Argentina: Médica Panamericana. 121134, 186-196
3. Yeo, I.-S., Yang, J.-H., & Lee, J.-B. (2003). In vitro marginal fit of three all ce ramic crown systems. Journal Prosthet Dent , 459-464.
4. Vojdani, M., Torabi, K., Farjood, E., & Khaledi, A. (2013). Comparison the marginal and internal fi t of metal copings cast from wax patterns fabricated by CAD/CAM and conventional wax up techniques. Journal Dent, 118-129.
Dentista y Paciente 20 Enciclopedia odontológica
5. Jieyin, L., Xihua, Y., Bohua, L., Juankun, L., Peilin, Z., & Jiantao, Y. (2015). Eff ect of oxidation heat treatment on the bond strength between a ceramic and cast and milled cobalt-chromium alloys. European Journal of Oral Sciences, 297-304.
6. Lombardo, G., Nishioka, R., & Souza, R. (2010). Infl uence of surface treatment on the shear bond strength of ceramics fused to cobalt–chromium. Journal Prosthodon, 103-111.
7. Wang, H., Feng, Q., Li, N., & Xu, S. (2016). Evaluation of metal-ceramic bond characteristics of three dental Co-Cr alloys prepared with diff erent fabrication techniques. Journal Prosthet Dent, 916-923.
8. Vojdani, M., Torabi, K., Farjood, E., & Khaledi, A. (2013). Comparison the marginal and internal fi t of metal copings cast from wax patterns fabricated by CAD/CAM and conventional wax up techniques. Journal Dent, 118-129.
9. Matta, E., Alarcon, M., & Matta, C. (2012). Espacio biológico y protesis fija: del concepto clásico a la aplicación tecnologica. Rev. Estomatol Herediana, 116-120.
10. Delgado, A., Inarejos, P., & Herrero, M. (2001). Espacio Biológico: La incersión del diente-encia. Periodon Implantol, 101-108.
11. Reyes, C., & Mosqueda, R. (2001). Consideraciones ideales en la toma de impresión dental. Revista ADM, 183-190.
12. Ramfjord, S., & Ash, M. (1982). Periodontología y Periodoncia. Buenos Aires: Ed. Panamericana.
13. Meola De Fex, J. (1991). Cambios dimensionales en los troqueles de yeso en impresiones con cofias acrílicas. Revista Ces Odontológica, 99-104.
14. Salazar, J. (2007). Métodos de separación gingival en protesis fija. Acta Odontológica Venezolana, 311-315.
15. Salazar, J. (1991). Los métodos de separación gingival y su relación con los tejidos periodontales. Odontología al día, 19-22.
16. Sepulveda, H., & Garzon, H. (2014). Toma de imprsiones en protesis fija, implicaciones periodontales. Avances Odontoestomatología, 83-95.
17. Gallardo, C., & Ascanio, A. (2020). Cofias dentales una propuesta con el uso de silicon para la impresión en la protesis parcial fija. Implantología Actual, 8-17.
18. Fisher, D. (1976). Conservative management of the gingival tissue for crowns. Dent Clin North Am, 273-284.
19. Villareal, E., Espias, A., Sanchez, L., & Sampaio, J. (2004). Manejo de tejidos gingivales, hemostasia y control del fluido crevicular: Paradigmas en odontología adhesiva contemporanea. Dentum, 14-21.
20. Ojeda, F., Márquez, R., Ramírez, J., Rojas, N., Martínez, R., Sánchez, P., & González, R. (2018). Estudio comparativo de tres materiales de impresión en su capacidad para reproducir el margen cervical de la preparación mediante las tecnicas de doble hilo y cofia de transferencia. Revista Odontológica Universitaria, 157-168.
189. Mayo 2024 21 Técnicas de desplazamiento gingival para una buena toma de impresión






La fresadora de quinta generación: Ceramill Matron de Amann Girrbach promete serious fun
Máxima precisión y excelente acabado de las superficies en un nuevo diseño para unos resultados excepcionales y diversión durante el trabajo artesanal

Dentista y Paciente 22 Boletín



Con la Ceramill Matron, Amann Girrbach llega al mercado la primera fresadora de quinta generación, con unas características avanzadas en comparación con las máquinas de las anteriores generaciones: una precisión extraordinaria, unos resultados de fresado sobresalientes y un manejo absolutamente intuitivo. Indicada para un amplio abanico de materiales, especialmente en el ámbito de los metales duros, la Ceramill Matron es adecuada para la ejecución autónoma de los pedidos gracias al cambiador de piezas en bruto de alto rendimiento que incorpora, para hasta ocho piezas en bruto, y puede integrarse completamente en el flujo de trabajo digital. Además, gracias a su facilidad de uso, la Ceramill Matron es la compañera óptima para todos los usuarios que buscan el máximo nivel de calidad, rentabilidad y diversión en el trabajo manual.
la Ceramill Matron conseguimos una suavidad de marcha nunca antes vista, lo que tiene un efecto extraordinariamente positivo en la calidad de la superficie y la vida útil de las fresas”, explica Leitner. Mediante la tecnología de 5 ejes Plus es posible realizar ángulos extremos, lo que se traduce también en una precisión muy alta en las socavaduras marcadas. La combinación del SnapMag, un portaherramientas magnético con 11 posiciones, con nuestra tecnología RFID hace que el cambio de herramientas sea rápido y cómodo. Mediante plug&play es posible colocar un número ilimitado de fresas de manera sencilla. Con un inteligente equipamiento previo con las herramientas necesarias es posible mecanizar muchos materiales sin necesidad de hacer cambios.
Trabajo autónomo y control intuitivo

La nueva fresadora Ceramill Matron de Amann Girrbach está óptimamente adaptada al mecanizado preciso y rápido de los metales duros, y está equipada con la última tecnología de herramientas y un vástago de la fresa de 3 o 6 mm. “La Ceramill Matron ofrece una experiencia digital totalmente novedosa y consigue unos resultados con una precisión a la altura de la de un centro de fresado. Incluso los metales duros como el titanio y el cromo cobalto de hasta 16 mm pueden mecanizarse sin problemas de manera interna”, explica Daniel Leitner, gestor de producto de Amann Girrbach.
MÁXima precisión de los detalles

La disposición en 45° de los ejes A/B asegura una rigidez y una precisión elevadas, con amortiguación de las vibraciones durante el fresado. “Con
El cambiador de piezas en bruto con capacidad para 8 unidades de la Ceramill Matron permite procesos de trabajo totalmente automáticos en el ámbito de la fabricación dental, con un control intuitivo de los procesos: una pantalla de 21.5 pulgadas guía al usuario con total comodidad a través de todos los pasos de trabajo, y asegura más diversión durante el trabajo diario. La integración de la fresadora en el flujo de trabajo digital es también muy sencilla. “Ceramill Matron es el producto perfecto para las clínicas y los laboratorios que desean impulsar la digitalización de sus flujos de trabajo y que son muy exigentes en cuanto a la calidad y la rentabilidad. Es precisamente esta combinación de rendimiento y diversión en el trabajo manual la que queremos transmitir a través del eslogan de nuestra campaña serious fun, subraya Leitner. Los primeros usuarios
189. Mayo 2����2�� 23
fresadora de quinta generación
La

de la nueva Ceramill Matron también se muestran entusiasmados. El maestro técnico dental Florian Barthel de la empresa HAL-Dent Zahntechnik GmbH en Halle (Alemania) opina: “La Ceramill Matron puede describirse con 4 palabras: intuitiva, potente, innovadora y multifuncional. En mi opinión, viene a cerrar la brecha entre la Ceramill Motion 3 y le Ceramill Matik y, gracias a su capacidad para integrar los desarrollos futuros, es una apuesta segura”. En Zeller Zahntechnik, en Ulm (Alemania), celebran la suavidad de marcha de la nueva máquina: “En nuestro laboratorio trabajamos mucho con cobalto-cromo y estamos impresionados por la suavidad de marcha de la Ceramill Matron durante el fresado de este material extraduro. Esto se traduce en una alta vida útil de las fresas y, por tanto, en una mayor eficacia de los recursos”.
Pinza de sujeción de 6 mm y su línea de fresas
Además de la opción probada del vástago de 3 mm, la fresadora ofrece también como complemento una pinza de sujeción de 6 mm y las correspondientes fresas, con un revestimiento de alto rendimiento de excelente calidad y adaptado a los respectivos materiales.
Los laboratorios y las clínicas dentales se benefician de unos tiempos de fresado notablemente más rápidos, especialmente en el mecanizado de los metales duros, de un desgaste de las herramientas reducido en un 50 por ciento y de una mayor estabilidad durante el fresado. Por eso, Ceramill Matron es una solución potente incluso para las tareas más complejas en la fabricación dental.
Para asegurar una flexibilidad máxima, Ceramill Matron puede equiparse en todo momento con una pinza de sujeción de 3 o 6 mm sin necesidad de cambiar el husillo. El uso y el cambio de la pinza de sujeción es sencillo y no entraña ningún riesgo, ya que la máquina guía paso a paso al usuario por todo el proceso a través de la amplia pantalla táctil.
Encontrará toda la información sobre los nuevos productos, aparatos y sistemas de software en www.amanngirrbach.com.
Amann Girrbach, una empresa pionera en la tecnología CAD/CAM dental, se ha convertido en una de las compañías innovadoras líderes y proveedoras de un servicio integral más populares de la odontología protésica digital. Con una gran competencia de desarrollo y una orientación consecuente hacia el cliente, esta empresa ofrece soluciones de flujo de trabajo sofisticadas, en las que los sistemas de software y la plataforma en la nube AG.Live desempeñan un papel clave. Materiales de alta calidad, un servicio técnico sólido con un Helpdesk global y ofertas de formación y capacitación completan la cartera de productos. Entre sus clientes en alrededor de 100 países se encuentran clínicas dentales, laboratorios clínicos y laboratorios dentales. En total, Amann Girrbach emplea a 560 trabajadores en todo el mundo. Además de los centros de desarrollo y producción en Koblach (sede) y Rankweil en Austria, Amann Girrbach posee filiales de venta en Pforzheim (D), Verona (IT), Jossigny (FR), Charlotte (EE. UU.), Singapur (ciudad), Curitiba (Brasil) y Pekín (China), así como cooperaciones en Kyoto (Japón) y Beirut (Líbano).
www.amanngirrbach.com
Dentista y Paciente 24 Boletín
Sobre Amann Girrbach

Serious Fun.
NUEVO: Cambiador de piezas en bruto de alto rendimiento totalmente automático, más rápido que nunca, en todos los materiales dentales, pantalla táctil de 21,5“ y mucho más. En amanngirrbach.com/seriousfun le contamos por qué la máquina Matron lleva la diversión a su laboratorio
DENTISTRY UNIFIED La fresadora de quinta generación
Amann Girrbach AG // Austria // Tel. +43 59 301 2100




















Punto de

Lupus y cavidad oral
Dentista y Paciente 28
vista
Fotoarte: Editorial Renascence | Fotografía: AdobeStock



En la actualidad la consulta odontológica puede ayudar a diagnos ti car diversas enfermedades, a partir de elaborar diagnósticos sistémicos presuntivos. Si bien la atención se debe concentrar en las prácticas operatorias, también debemos tomar en cuenta que no todos los pacientes pueden estar sistémicamente sanos y por tanto pueden reaccionar a los tratamientos bucales de manera diferente. En el caso del lupus eritematoso sistémico (LES) el paciente se ve envuelto en una serie de cambios sistémicos que afectan todo su organismo.
Se debe tener presente que al estar involucrado el sistema inmune los procesos de rehabilitación pueden ser distintos a lo esperado.
El paciente con LES en muchas ocasiones puede tener manifestaciones en el medio bucal, que el odontólogo está obligado a conocer y saber cómo tratar en forma adecuada, así como conocer los límites de atención a este tipo de pacientes.
189. Mayo 2024 29 Lupus y cavidad oral
C.D. Isis G. Villavicencio
Punto de vista
El paciente con LES en muchas ocasiones puede tener manifestaciones en el medio bucal, que el odontólogo está obligado a conocer y saber cómo tratar en forma adecuada, así como conocer los límites de atención a este tipo de pacientes.
Desarrollo
El lupus eritematoso sistémico, es una enfermedad poco conocida, autoinmune y aunque su etiología es desconocida, existen diversos factores que pueden favorecer al desarrollo de dicho padecimiento, entre estos factores podremos encontrar

principalmente la radiación ultravioleta o factores genéticos. A pesar de que existen diferentes estudios para determinar la causa de la enfermedad, aún no se llega a una conclusión en común ya que pueden ser muchas las variables que intervienen para su desarrollo, una de las causas de las que se toma mucha importancia es el estrés al cual está sometido el individuo, ya que este pudiera nacer con la predisposición a padecer el LES, pero con el estrés podría empezar a manifestar los cuadros de la enfermedad.
La prevalencia de esta enfermedad frecuentemente está ligada al sexo ya que las mujeres en edad reproductiva tienen mayor predisposición a padecerlo; de igual modo, la raza puede ser un factor determinante ya que suele ser más frecuente en pacientes de ascendencia afroamericana e hispana.
Sus expresiones clínicas pueden ser muy variadas ya que el LES se distingue por 2 periodos uno subclínico, seguido de una fase clínica en los cuales se ven manifestados los signos y síntomas de la enfermedad. Entre los síntomas generales podemos encontrar fiebre, pérdida de peso, debilidad,1 fatiga crónica, pérdida del apetito y los síntomas más orgánicos y característicos de la enfermedad son: artritis,
Dentista y Paciente 30
artralgia, síndrome de Sjögren (de vital importancia odontológica), fenómeno de Raynaud, manifestaciones mucocutáneas, afecciones neuropsiquiátricas, manifestaciones cardiovasculares y pulmonares así como la más característica afecciones renales.
Las lesiones bucales en el lupus suelen ser asintomáticas, razón por lo que generalmente pasan desapercibidas, de aquí la importancia del examen clínico bucal sistematizado y de rutina para estos pacientes. El tamaño de las lesiones es variable, las úlceras por ejemplo pueden ir desde una pequeña erosión superficial hasta un área francamente ulcerada, larga y grande.
Algunos pacientes podrían mostrar lesiones asociadas a hiperpigmentación, lo que pudiera tener explicación en el uso de antimaláricos (medicamento de uso frecuente en pacientes con lesiones en piel), ya que su consumo prolongado puede inducir pigmentaciones reversibles tanto en piel como en mucosa.
Manejo odontológico:
Generalmente el paciente que acude a la consulta odontológica conoce su diagnóstico y alguna de las limitaciones que le produce dicha patología; sin embargo, es el odontólogo quien debe establecer los parámetros para su atención).2 En primer lugar, la elaboración de una adecuada historia clínica es fundamental para brindarle a este tipo de pacientes un excelente tratamiento pudiendo dar soluciones a sus necesidades, considerando los riesgos potenciales durante la intervención y las medidas preventivas que sean necesarias para que resulte favorable.
La historia clínica debe iniciar con una anamnesis que mencione datos referentes a la patología sistemática que padece y el respectivo tratamiento farmacológico, debe ir seguida de un examen clínico detallado de los tejidos duros y blandos de la cavidad bucal. Como no existe un manejo específico, el programa de tratamiento debe ir acorde a las manifestaciones de cada paciente en particular, dependiendo fundamentalmente del tipo de manifestación, severidad, actividad y existencia de otros problemas asociados como embarazo e infecciones.

189. Mayo 2024 31 Lupus y cavidad oral
Punto de vista
El tratamiento para el LES es principalmente preventivo, la reversión de la inflamación, el mantenimiento de los estados de la remisión y el alivio de los síntomas, el odontólogo debe procurar prescribir tratamientos farmacológicos que no sean metabolizados renalmente.
Es de vital importancia una constante comunicación con el médico tratante para así lograr un mejor desarrollo del tratamiento, ya que es necesaria la eliminación de cualquier foco infeccioso en la cavidad bucal, de no ser así se estaría suprimiendo el tratamiento inmunodepresor y además creando predisposición a infecciones secundarias.
Conclusión
Ya que el LES es una enfermedad multisistémica es importante identificar los signos y síntomas de esta debido a que en los últimos años ha aumentado la incidencia de los pacientes con este padecimiento. En el consultorio odontológico es de vital importancia saber diferenciar cada patología, para así poder ayudar al diagnóstico precoz del lupus eritematoso sistémico.
No a todos los pacientes les afecta en la mucosa bucal, pero en la primera fase de la enfermedad es frecuente que aparezcan algunas lesiones indoloras, a las cuales el odontólogo debe diagnosticar, tratar o diferenciar de alguna otra entidad clínica.
Referencias
1. https://rheumatology.org/patients/lupus-espanol
2. José Luis Castellanos Suarez, Laura María Díaz Guzmán, Oscar Zarate Medicina en odontología capitulo 11 pag 206 enfermedades inmunitarias.
3. López-Labady J; Moret Y; Villarroel Dorrego M; Mata de Henning, M. Manifestaciones orales del lupus eritematoso sistémico; acta odontológica venezolana. venez V45 n.2 Caracas 2007
4. Secretaria de salud; Boletín epidemiológico, sistema nacional de vigilancia epidemiológica. Numero 30, volumen 30, semana 30, del 21 al 27 de julio 2013
5. Margarita Enberg, Mariana Kahn, Cecilia Goity. Infecciones en pacientes con lupus eritematoso sistemico. rev med chile 2009; 137; 1367-1374
6. Noguera A. Lupus Eritematoso Sistémico. 1era ed. Mérida: Consejo de Publicaciones Universidad de Los Andes; 1994.
Dentista y Paciente 32








































































Teleodontología: un método para optimizar la atención dental






Punto de vista Dentista y Paciente 34 Calidad y dirección
Fotoarte: Editorial Renascence | Fotografía: AdobeStock / Andrii Yalanskyi

Teledentistry: A Method for Optimizing Dental care
Lussi Y. Ronquillo Aguilar, DDS. New York University/Dentistry DDS Candidate, 2024 Email:lyd7738@nyu.edu
Maria P. Rodriguez Cardenas. DDS, FACD Clinical Assistant Professor NYU/Dentistry 345 East 24th Street New York, NY 10010 Email:mpr217@nyu.edu
La odontología es un método relativamente nuevo para proporcionar atención dental que implica el uso de tecnología para ofrecer diagnósticos y consultas a distancia. Los profesionales pueden ofrecer diagnósticos limitados e instrucciones de tratamiento a los pacientes a través de plataformas digitales.
Teledentistry is a relatively new method of providing dental care that involves using technology to provide remote diagnosis, and consultation. Practitioners can provide limited diagnosis and patient instruction for treatment via digital platforms.
189. Mayo 2024 35 Teleodontología: un método para optimizar la atención dental
Calidad y dirección
Este método de consulta ha ganado popularidad en los últimos años, especialmente durante la pandemia de COVID-19. Proporciona una forma segura y conveniente para que los pacientes accedan a una atención dental limitada. Como profesionales, debemos evaluar las implicaciones positivas y negativas de esta metodología. Debemos proteger la privacidad del paciente y proporcionar a nuestros pacientes el entendimiento de las posibles limitaciones de este método. En algunos casos, es esencial que los pacientes realicen un seguimiento con una consulta clínica cara a cara. Nuestra intención es examinar los beneficios y limitaciones potenciales de la teleodontología como método para optimizar una práctica dental, incluso en el periodo pospandémico.
Métodos
Algunos estudios han demostrado que la teleodontología es efectiva para reducir la carga en los departamentos de emergencia 1,2 (Islam MRR, Islam R, Ferdous S, Watanabe C, Yamauti M, Alam MK, Sano H) y aumentar

This method of consultation has gained increased popularity in recent years, especially during the COVID-19 pandemic. It provides a safe and convenient way for patients to access limited dental care. As practitioners, we need to evaluate the positive and negative implications of this methodology. We must be protect patient privacy, and provide our patients the understanding of possible limitations of this methodology. In some cases, it is essential for patients to follow up with a faceto-face clinical consultation. It is our intention to examine the potential benefits and limitations of teledentistry as a method for optimizing a dental practice, even in the post-pandemic period.
METHoDs
The COVID-�������� ��������e������ accelerated the adoption of a teledentistry assessment as a means of providing dental care to patients while maintaining social distancing measures.

Studies have shown that teledentistry is effective in reducing the burden on emergency departments1,2 (Islam MRR, Islam R, Ferdous S, Watanabe C, Yamauti M, Alam MK, Sano H;) and increasing access to dental care for patients, especially those in rural and underserved areas 3 (University of Rochester’s Eastman Institute for Oral Health, https://doi. org/10.1377/hlthaff.2018.05102). The use of telehealth technology has been found to be efficient, and also at times limiting in diagnosing dental conditions. A Teledentistry appointment provides patients with a prompt evaluation of possible diagnosis, treatment and care .Its’ efficiency is optimized when the patient follows up in a clinical setting. Teledentistry may be a cost-effective method for delivering dental care, as it reduces the travel costs for patients.
Teledentistry access has the potential to improve patient outcomes by allowing dental providers to monitor
Dentista y Paciente 36
el acceso a la atención dental para los pacientes, especialmente aquellos en áreas rurales y desatendidas3 (Instituto de Salud Bucal Eastman de la Universidad de Rochester, https://doi. org/10.1377/hlthaff.2018.05102).
Se ha encontrado que el uso de la tecnología de telemedicina ha sido eficiente, aunque a veces limitante, en el diagnóstico de condiciones dentales. Una cita de teleodontología proporciona a los pacientes una evaluación rápida de posibles diagnósticos, tratamientos y cuidados. Su eficiencia se optimiza cuando el paciente hace seguimiento en un entorno clínico. La teleodontología puede ser un método rentable para ofrecer atención dental, ya que reduce los costos de viaje para los pacientes.
El acceso a distancia de la odontología tiene el potencial de mejorar los resultados de los pacientes al permitir a los proveedores dentales monitorear a sus pacientes de forma remota, lo que resulta en una intervención temprana y una mejor gestión del cuidado. La teleodontología también puede mejorar la satisfacción del paciente, pues los pacientes pueden acceder a la atención dental desde la comodidad de sus hogares, sin la necesidad de tomar permisos en el trabajo o la escuela.
Los pacientes necesitan acceso a esta tecnología a través de teléfonos inteligentes personales, redes informáticas o asistir a ubicaciones centralizadas donde haya acceso a internet. Esto puede ser escuelas, bibliotecas, hogares de ancianos, instalaciones de cuidado infantil u hogares grupales. El practicante tiene más limitaciones y necesidades en los Estados Unidos con una infraestructura segura y compatible con HIPAA. Las reglas y limitaciones
their patients remotely, resulting in early intervention and improved care management. Teledentistry can also improve patient satisfaction, as patients can access dental care from the comfort of their own homes, without the need to take time off from work or school.
Patients need access to this technology via personal smart phones, computer networks, or attend centralized locations where internet access is available. This may be schools, libraries, nursing homes, childcare facilities, or group homes. The practitioner has more limitations and needs in the United States a secure HIPAA(privacy) compliant infrastructure. Rules and limitations vary depending on the state that provides service in the United States.
The COVID-19 pandemic accelerated the adoption of a teledentistry assessment as a means of providing dental care to patients while maintaining social distancing measures. This led to increased awareness and acceptance of teledentistry among patients and dental professionals.
Teledentistry provides several benefits, including increased patient access to dental care, and improved patient satisfaction.4
Reduced time and costs associated with travel to dental offices. Teledentistry improved patient engagement, education and can streamline the diagnostic, and treatment process, making it more efficient for dental professionals.
It is important to highlight the need for better education and training for dental practitioners on the use of teledentistry. As the world continues to deal with the pandemic and
189. Mayo 2024 37 Teleodontología: un método para optimizar la atención dental
Tabla 1. Satisfacción del paciente con el proceso de teleconsulta (n = 24). La satisfacción fue evaluada del 4 al 10 (4 = peor. 10 = mejor) Tabla 1,4 Emami, E., Harnagea, H., Shrivastava, R. et al. Patient satisfaction with e-oral health care in rural and remote settings: a systematic review.
Syst Rev 11, 234 (2022). https://doi. org/10.1186/s13643-022-02103-2; 5, 6, 7)
Table 1. Patient satisfaction with the teleconsultation proces (n=24).
Satisfactionwas graded from 4 to 10 (4=worst to 10 = best). (Table 1,4 Emami, E., Harnagea, H., Shrivastava, R. et al. Patient satisfaction with e-oral health care in rural and remote settings: a systematic review. Syst Rev 11, 234 (2022). https://doi. org/10.1186/s13643-022-02103-2; 5, 6, 7;)
varían dependiendo del estado que brinda servicio en los Estados Unidos.
La pandemia de COVID-19 aceleró la adopción de una evaluación de teleodontología como medio para proporcionar atención dental a los pacientes mientras se mantienen las medidas de distanciamiento social. Esto llevó a un mayor conocimiento y aceptación de la teleodontología entre los pacientes y los profesionales dentales.
La teleodontología ofrece varios beneficios, incluido un mayor acceso de los pacientes a la atención dental y una mayor satisfacción del paciente.4
La teleodontología reduce el tiempo y los costos asociados con los viajes a los consultorios dentales. Además, mejora la participación del paciente, la educación y puede optimizar el proceso de diagnóstico y tratamiento, haciéndolo más eficiente para los profesionales dentales.
Es importante resaltar la necesidad de una mejor educación y capacitación para los profesionales dentales en el uso de la teleodontología. A medida que el mundo continúa lidiando con la pandemia y la importancia de la atención médica remota sigue creciendo, es imprescindible que los profesionales dentales adopten e integren la teleodontología en su práctica. Esto no solo ayudará a mantener la seguridad y atención del paciente, sino que también
the importance of remote healthcare continues to grow, it is crucial for dental professionals to adopt and integrate teledentistry into their practice. This will not only help maintain patient safety and care, but it will also help to ensure the sustainability of dental practices during challenging times.
To enhance the dental practitioners' knowledge and practice of teledentistry, various initiatives could be undertaken, such as:
1. Continuing education and training programs to educate dental practitioners on the use of telemedicine technologies, the legal and ethical implications of teledentistry, and the best practices for delivering remote dental care.
2. Providing resources and support to dental practitioners who are new to teledentistry, such as access to online courses, videos, and tutorials, to help them learn and implement teledentistry in their practices.
3. Collaborating with telemedicine organizations and experts to share best practices and provide education and support to dental practitioners on the use of telemedicine technologies in dentistry.
4. Developing guidelines and standards for teledentistry practices to ensure that patients receive
Dentista y Paciente 38
Calidad y dirección
Hospital (km) / Hospital (km) 4 5 6 7 8 9 10 Total 21-34 0 0 0 1 2 1 0 4 35-49 0 0 0 0 2 2 0 4 50-64 0 0 0 0 3 5 1 9 >64 0 0 0 0 0 6 1 7 Total 0 0 0 1 7 14 2 24
Distancia desde la casa del paciente / Distance of patient residence from Índice de satisfacción / Satisfaction score
contribuirá a garantizar la sustentabilidad de las prácticas dentales durante tiempos difíciles.
Para mejorar el conocimiento y la práctica de la teleodontología por parte de los profesionales dentales, se podrían emprender diversas iniciativas, tales como:
1. Programas de educación continua y capacitación para educar a los profesionales dentales sobre el uso de tecnologías de telemedicina, las implicaciones legales y éticas de la teleodontología y las mejores prácticas para brindar atención dental remota.
2. Proporcionar recursos y apoyo a los profesionales dentales que son nuevos en la teleodontología, como acceso a cursos en línea, videos y tutoriales, para ayudarles a aprender e implementar la teleodontología en sus prácticas.

La pandemia de COVID-�������� aceleró la adopción de una evaluación de teleodontología como medio para proporcionar atención dental a los pacientes mientras se mantienen las medidas de distanciamiento social.

care
means.
Patient assessment via teledentistry has been a game changer in the practice of dentistry. It has provided






��
Teleodontología: un método para optimizar la atención dental
through remote
39
Calidad y dirección
1. ¿Adecuación de la tecnología de videoconferencia para consultas? /
1. Suitability of videoconferencing technology for consultations?
2. ¿Calidad de las imágenes de radiografías dentales mostradas a través de videoconferencia? /
2. Quality of dental X-ray images shown via videoconferencing
3. ¿Adecuación de la videoconferencia para mostrar modelos de yeso dental? /
3. Suitability of videoconferencing for showing dental castor models?
4. ¿Adecuación de la videoconferencia para mostrar fotografías orales? /
4. Suitability of videoconferencing for showing dental oral photographs?
5. ¿Adecuación de la videoconferencia para realizar entrevistas a pacientes? /
Suitability of videoconferencing for conducting patient interviews?
6. ¿Cómo funcionó la sesión de teleconsulta como proceso de aprendizaje? /
6. How did teleconsultation session function as a learning process?
7. ¿Funcionamiento general de la videoconferencia (escala de 4 a 10)? /
Overall functioning of videoconferencing (scale 4-10)?
Tabla 2. La satisfacción del usuario para 23 profesionales dentales con respecto al uso de videoconferencias en la teleconsulta dental. La satisfacción fue evaluada del 1 al 5 (1 = muy malo, 5 = muy bueno), excepto para la pregunta 7 (escala de 4 a 10, donde
4 = peor, 10 = mejor) (Tabla 2,4 Emami, E., Harnagea, H., Shrivastava, R. et al. Patient satisfaction with e-oral health care in rural and remote settings: a systematic review.
Syst Rev 11, 234 (2022). https://doi. org/10.1186/s13643-022-02103-2; 5, 6, 7.)
Table 2. User satisfaction for 23 dental professionals concerning the use of videoconferencing in dental teleconsultation. Satisfaction was graded from 1 to 5 (1= very bad to 5 = very good), except for question 7 (scale 4-10, 4 = worst, 10 = best). (Table 2,4 Emami, E., Harnagea, H., Shrivastava, R. et al. Patient satisfaction with e-oral health care in rural and remote settings: a systematic review.
Syst Rev 11, 234 (2022). https://doi. org/10.1186/s13643-022-02103-2; 5, 6, 7.)
3. Colaborar con organizaciones y expertos en telemedicina para compartir las mejores prácticas y proporcionar educación y apoyo a los profesionales dentales sobre el uso de tecnologías de telemedicina en la odontología.
4. Desarrollar pautas y estándares para las prácticas de teleodontología para garantizar que los pacientes reciban atención de alta calidad a través de medios remotos.
La evaluación de pacientes a través de la teleodontología ha sido un
an alternative for dental professionals to connect with their patients, regardless of their physical location. Teledentistry has been used for a variety of purposes, including triage, follow-up care, and non-procedural care12, 13(Alabdullah JH, Daniel SJ. A Systematic Review on the Validity of Teledentistry. Telemed J E Health PMID: 29303678. Fernández CE, Maturana CA, Coloma SI, Teledentistry and mHealth for Promotion and Prevention of Oral Health: A Systematic Review and Meta-analysis. PMID: 33769123.)
The implementation of teledentistry has not been without its challenges. The technological infrastructure requires the right equipment, software, and internet connectivity to be in place. Another challenge is the skill level of the provider, who must be able to use technology effectively to provide quality assessment and care. Additionally, billing issues and privacy concerns are a concern. There are still questions around how
Dentista y Paciente 40
Pregunta
Question Puntuación media / Puntuación media DE / SE
/
4.6 0.63
4.4 0.81
4.2 0.76
4.6 0.77
4.9 0.73
5.
4.6 0.90
8.7 0.86
7.
cambio de juego en la práctica de la odontología. Ha proporcionado una alternativa para que los profesionales dentales se conecten con sus pacientes, independientemente de su ubicación física. La teleodontología se ha utilizado para una variedad de propósitos, incluyendo triaje, atención de seguimiento y atención no procedimental.12,13 (Alabdullah JH, Daniel SJ. A Systematic Review on the Validity of Teledentistry. Telemed J E Health PMID: 29303678. Fernández CE, Maturana CA, Coloma SI, Teledentistry and mHealth for Promotion and Prevention of Oral Health: A Systematic Review and Meta-analysis. PMID: 33769123).
La implementación de la teleodontología no ha estado exenta de desafíos. La infraestructura tecnológica requiere que estén en su lugar el equipo adecuado, el software y la conectividad a internet. Otro desafío es el nivel de habilidad del proveedor, quien debe ser capaz de utilizar la tecnología de manera efectiva para proporcionar una evaluación y atención de calidad. Además, los problemas de facturación y las preocupaciones de privacidad tienen su carga de inquietud. Todavía hay preguntas sobre cómo las compañías de seguros reembolsarán por los servicios de teleodontología y cómo garantizar
insurance companies will reimburse for teledentistry services and how to ensure the privacy and security of patient information during virtual synchronous and asynchronous consultations. Every state has specific guidelines as to the proper practice of the dental profession. This applies to teledentistry consultations and follow up care.
Figura 1. Gráfica de pastel para mostrar experiencias previas con la telemedicina.
Figure 1. A pie chart to show previous experience with telehealth.
La implementación de la teleodontología no ha estado exenta de desafíos. La infraestructura tecnológica requiere que estén en su lugar el equipo adecuado, el software y la conectividad a internet.
189. Mayo 2024 41
Teleodontología: un método para optimizar la atención dental
Sí / Yes No / No 21% 79%
Calidad y dirección
A la luz de la pandemia por coronavirus, consideraría consultas en clínica virtual en el futuro. / In light of the coronavirus pandemic, I would consider future consultations via visual clinic La clínica virtual me ahorró tiempo (en transporte, trabajo u otros) / The virtual clinic save me time (travel, work or other commitments)
Fui capaz de acceder a la clínica virtual / I was able to access the virtual clinic
No tuve ningún problema de conección / I did not have any connection issues
Pude hablar con los clínicos tan bien como en personaI/ coul talk to the clinician as well as if we met in person
Me pude expresar de manera efectiva/ I was able to express myself effectively
Pude hablar y escuchar fácilmente con el clínico/ I could easily hear and talk to the clinician
El sistema fue fácil de usar/ The system was easy to use
La clínica virtual satisfizo mis necesidades/ The virtual clinic met me needs
Usaría la clínica virtual de nuevo/ I would use the virtual clinic again
Definitivamente de acuerdo / Definnitely agree De acuerdo / Agree Ni de acuerdo ni en desacuerdo/ Neither agree nor disagree En desacuerdo /Disagree Definitivamente en desacuerdo /Definitely disagree
la privacidad y seguridad de la información del paciente durante las consultas virtuales sincrónicas y asincrónicas. Cada estado tiene pautas específicas sobre la práctica adecuada de la profesión dental. Esto se aplica a las consultas y atención de seguimiento de la teleodontología.
Otra limitación de la teleodontología es la falta de retroalimentación táctil, y el hecho de que la teleodontología puede no ser apropiada para todos los pacientes o todas las condiciones dentales; la examinación cara a cara es esencial en ciertos escenarios clínicos.
Another limitation to teledentistry is the lack of tactile feedback, and the fact that teledentistry may not be appropriate for all patients or all dental conditions; face-to-face examination is essential in certain clinical scenarios.
Despite these challenges, teledentistry has shown to be a promising tool for improving access to dental care, especially in remote areas8 (Accuracy and effectiveness of teledentistry: A systematic review of systematic reviews. Nalia Gurgel-Juarez, Cassius Torres-Pereira, Ana E. Haddad). With ongoing improvements in technology and
Dentista y Paciente 42
Figura 2. Resultados de la encuesta de la clínica virtual.
Figure 2. Virtual clinic survey results.
A pesar de estos desafíos, la teleodontología ha demostrado ser una herramienta prometedora para mejorar el acceso a la atención dental, especialmente en áreas remotas8 (Accuracy and effectiveness of teledentistry: A systematic review of systematic reviews. Nalia Gurgel-Juarez, Cassius Torres-Pereira, Ana E. Haddad). Con mejoras continuas en la tecnología y el aumento de las habilidades del proveedor, es probable que la teleodontología continúe desempeñando un papel importante en el futuro de la atención dental.
Por ejemplo, la teleodontología en el manejo del cáncer oral y de cabeza y cuello puede mejorar significativamente el pronóstico de estas enfermedades. Al permitir el monitoreo regular y las consultas remotas, el enfoque de la teleodontología puede ayudar a los pacientes a recibir atención de manera oportuna, sin necesidad de viajar o esperar largos periodos de tiempo. De esta manera, estamos mejorando el acceso de los pacientes a la atención, reduciendo la carga sobre el sistema de salud y aumentando la satisfacción del paciente. Sin embargo, aún existen desafíos, como la privacidad, la seguridad de los datos y las limitaciones tecnológicas.
A pesar de estos posibles beneficios, el uso de la teleodontología en el manejo del cáncer oral y de cabeza y cuello sigue siendo relativamente nuevo, y se necesita más investigación para comprender completamente su impacto en los resultados del paciente y la calidad de la atención9 (Da Silva HEC, Santos GNM, Leite AF., The role of teledentistry in oral cancer patients during the COVID-19 pandemic: an integrative literature review. 2021 Dec;29(12): PMCID: PMC8255116). Es importante
increasing provider skills, it is likely that teledentistry will continue to play an important role in the future of dental care.
For example, teledentistry in the management of oral and head and neck cancer can greatly improve the prognosis of these diseases. By enabling regular monitoring and remote consultations, the teledentistry approach can help patients receive care in a timely manner, without the need for travel or long wait times. Thus ,we are improving patient access to care, reduce the burden on the healthcare system, and increase patient satisfaction.


189. Mayo 2����2�� 43
Teleodontología: un método para optimizar la atención dental
Calidad y dirección
A la luz de la pandemia por coronavirus, consideraría consultas en clínica virtual o telefónica en el futuro / In light of the coronavirus pandemic, I would consider future consultations via virtual clinic or telephone La consulta telefónica me ahorró tiempo (en transporte, trabajo u otros) / The telephone consultation save me time (travel, work or other commitments)
Fui capaz de acceder a la consulta telefónica / I was able to access the telephone consultation
No tuve ningún problema de recepción telefónica / I did not have any phone reception issues
Pude hablar con los clínicos tan bien como en persona/ I coul talk to the clinician as well as if we met in person
Me pude expresar de manera efectiva/ I was able to express myself effectively
Pude hablar y escuchar fácilmente con el clínico/ I could easily hear and talk to the clinician
El sistema fue fácil de usar/ The system was easy to use La clínica virtual satisfizo mis necesidades/ The virtual clinic met me needs
Usaría la clínica virtual de nuevo/ I would use the virtual clinic again
Definitivamente de acuerdo / Definnitely agree De acuerdo / Agree Ni de acuerdo ni en desacuerdo/ Neither agree nor disagree En desacuerdo /Disagree Definitivamente en desacuerdo /Definitely disagree
también asegurarse de que los enfoques de la teleodontología se integren con los sistemas de atención médica existentes y se utilicen en conjunto con evaluaciones y tratamientos tradicionales en persona.
Este alto nivel de satisfacción entre los pacientes de medicina oral que utilizan por primera vez los servicios de teleodontología durante la pandemia de COVID-1911 (Figura 1, Figura
2, Figura 3, N, Nathwani S, Kandiah T. Teledentistry desde una perspectiva del paciente durante la pandemia de coronavirus), indica una implementación exitosa de la tecnología en el
However, challenges still exist, such as privacy, data security, and technology limitations.
Despite these potential benefits, the use of teledentistry in the management of oral and head and neck cancer remains relatively new, and further research is needed to fully understand its impact on patient outcomes and quality of care9 (Da Silva HEC, Santos GNM, Leite AF., The role of teledentistry in oral cancer patients during the COVID-19 pandemic: an integrative literature review. 2021 Dec;29(12): PMCID: PMC8255116). It is also important to ensure that teledentistry approaches
Dentista y Paciente 44
Figura 3. Resultados de la encuesta de la clínica telefónica.
Figure 3. Telephone clinic survey result.

campo de la medicina oral y podría conducir a un cambio hacia un uso más generalizado de la teleodontología en el futuro.
(Figura 1; Figura 2; Figura 3; Figura 3 N, Nathwani S, Kandiah T. Teledentistry desde la perspectiva del paciente durante la pandemia de coronavirus. Br Dent J. 2020 PMCID: PMC7427495). Este alto nivel de satisfacción resalta el potencial de la tecnología en la prestación de atención dental de calidad12 (Alabdullah JH, Daniel SJ. Una revisión sistemática sobre la validez de la teledentistry. Telemed J E Health PMID: 29303678). La conveniencia de recibir atención desde la comodidad del hogar y la comunicación efectiva entre los pacientes y sus profesionales dentales han convertido a la teleodontología en una alternativa viable a las citas tradicionales en persona.
are integrated with existing healthcare systems and are used in conjunction with traditional in-person evaluations and treatments.
This high level of satisfaction among first time oral medicine patients with teledentistry services during the COVID-19 pandemic11 (Figure 1; Figure 2; Figure 3; N, Nathwani S, Kandiah T. Teledentistry from a patient perspective during the coronavirus pandemic), indicates a successful implementation of technology in the oral medicine field and may lead to a shift towards more widespread use of teledentistry in the future.
(Figure 1; Figure 2; Figure 3; Figure 3 N, Nathwani S, Kandiah T. Teledentistry from a patient perspective during the coronavirus pandemic. Br Dent J. 2020 PMCID: PMC7427495). This high level of satisfaction, highlights the potential of technology




















































189.Mayo 2����2�� 45 Teleodontología: un método para optimizar la atención dental
La teleodontología tiene el potencial de optimizar nuestras prácticas dentales, incluso en el periodo pospandémico, al aumentar el acceso a la atención dental, mejorar los resultados para los pacientes y reducir los costos.
Este resultado demuestra la importancia de adaptarse a circunstancias cambiantes y utilizar la tecnología para continuar proporcionando servicios de atención médica esenciales. La pandemia de COVID-19 ha creado una nueva realidad para los proveedores de atención médica, y la teleodontología ha sido capaz de llenar un vacío en el acceso a la atención dental para los pacientes. Ha destacado la importancia de adaptarse a circunstancias cambiantes y utilizar la tecnología para proporcionar servicios de atención médica esenciales.
En cuanto a la toma de decisiones clínicas que involucran la teleodontología, la evidencia actual13 (Fernández CE, Maturana CA, Coloma SI, Teledentistry and mHealth for Promotion and Prevention of Oral Health: A Systematic Review and Meta-analysis. PMID: 33769123) respalda la teleodontología como un medio efectivo para las referencias dentales, el cumplimiento de la planificación del tratamiento y la viabilidad del mismo. La comunicación asincrónica (grabar, guardar y cargar) y la adopción de teléfonos inteligentes para la captura de imágenes son factibles y convenientes para la implementación de la teleodontología. La comunicación en tiempo real es esencial al proporcionar atención de emergencia.
El conocimiento moderado y la práctica deficiente de la teleodontología por parte de los profesionales
in providing quality dental care 12 (Alabdullah JH, Daniel SJ. A Systematic Review on the Validity of Teledentistry. Telemed J E Health PMID: 29303678). The convenience of receiving care from the comfort of one's own home and the effective communication between patients and their dental professionals have made teledentistry a viable alternative to traditional in-person appointments.
This result demonstrates the importance of adapting to changing circumstances and utilizing technology to continue providing essential healthcare services. The COVID-19 pandemic has created a new reality for healthcare providers, and teledentistry has been able to fill a gap in access to dental care for patients. It has highlighted the importance of adapting to changing circumstances and utilizing technology to provide essential healthcare services.
Regarding clinical decision-making involving teledentistry, current evidence 13 (Fernández CE, Maturana CA, Coloma SI, Teledentistry and mHealth for Promotion and Prevention of Oral Health: A Systematic Review and Meta-analysis. PMID: 33769123) supports teledentistry as an effective means for dental referrals, treatment planning compliance and treatment viability. Asynchronous (record, save and upload) communication and the adoption of smartphones for image capturing are
Dentista y Paciente 46
Calidad y dirección

Calidad y dirección
dentales durante la pandemia de COVID-19 resaltaron la necesidad de mejores programas de educación y capacitación para mejorar su conocimiento y práctica de la teleodontología14 (https://adea.org/Press/ Oct2021-Full-Promise-of-Teledentistry-Hinges-on-Dental-Education).
Con la creciente importancia de la atención médica remota, los profesionales dentales deben adoptar e integrar la teleodontología en su práctica para asegurar la sustentabilidad de sus consultorios y proporcionar atención de alta calidad a sus pacientes. La teleodontología es un cambio de juego para cerrar algunas de las brechas existentes en el acceso a la atención. Se necesita planificar y ejecutar un conjunto bien estructurado de acciones. Esto incluye el desarrollo e implementación de programas de educación en teleodontología, así como la incorporación de tecnología teledental en la práctica clínica. Además, es importante involucrarse con los proveedores de seguros y pagadores para asegurar que los servicios teledentales sean reembolsados de la misma manera que los servicios en persona.
Para lograr la paridad, también es esencial asegurar que los servicios teledentales sean accesibles y asequibles para todas las poblaciones, independientemente de su ubicación o estatus socioeconómico. Esto se puede lograr trabajando con sistemas de entrega de salud para integrar la tecnología teledental en la infraestructura existente y desarrollar programas teledentales para llegar a las comunidades desatendidas.
Es importante establecer pautas y regulaciones claras para las consultas teledentales para garantizar la seguridad y privacidad del paciente. Esto incluye asegurar que los practicantes
feasible and convenient for the implementation of teledentistry. Synchronous(real time) communication is essential when providing emergency care.
Dental practitioners' moderate knowledge and poor practice of teledentistry during the COVID-19 pandemic highlighted the need for better education and training programs to enhance their knowledge and practice of teledentistry 14 (https://adea.org/Press/ Oct2021-Full-Promise-of-Teledentistry-Hinges-on-Dental-Education).
With the increasing importance of remote healthcare, dental professionals must adopt and integrate teledentistry into their practice to ensure the sustainability of their practices and provide high-quality care to their patients.
Teledentistry is a game changer to close some of the existent gaps in access to care. A well-structured set of actions needs to be planned and executed. This includes developing and implementing tele-dental education programs, as well as incorporating tele-dental technology into clinical practice. Additionally, it is important to engage with insurance providers and payers to ensure that tele-dental services are reimbursed at the same rate as in-person services.
To achieve parity, it is also essential to ensure that tele-dental services are accessible and affordable to all populations, regardless of location or socioeconomic status. This can be accomplished by working with health delivery systems to integrate tele-dental technology into the existing infrastructure and developing tele-dental programs to reach underserved communities.
Dentista y Paciente 48
teledentales tengan la formación, licencias y certificaciones necesarias para proporcionar atención de alta calidad, y que el equipo y software teledental cumplan con los estándares de la industria en términos de calidad y seguridad.
Conclusión
La teleodontología tiene el potencial de optimizar nuestras prácticas dentales, incluso en el periodo pospandémico, al aumentar el acceso a la atención dental, mejorar los resultados para los pacientes y reducir los costos. Sin embargo, se necesita más investigación para comprender completamente las limitaciones y beneficios de la teleodontología, y para determinar las mejores formas de integrar esta tecnología en la práctica dental.
Lograr la paridad en la teleodontología requiere colaboración entre los sistemas de entrega de salud, los interesados en la salud bucal y los responsables de formular políticas para garantizar que los servicios teledentales sean accesibles, asequibles y seguros para todos los pacientes. La odontología académica tiene un papel importante que desempeñar al liderar este cambio y preparar a la próxima generación de dentistas para que adopten y utilicen la tecnología teledental.
It is important to establish clear guidelines and regulations for tele-dental consultations to ensure patient safety and privacy. This includes ensuring that tele-dental practitioners have the necessary training, licensing, and certifications to provide high-quality care and that tele-dental equipment and software meet industry standards for quality and security.
Conclusion
Teledentistry has the potential to optimize our dental practices, even in the post-pandemic period, by increasing access to dental care, improving patient outcomes, and reducing costs. However, further research is needed to fully understand the limitations and benefits of teledentistry, and to determine the best ways to integrate this technology into dental practice.
Achieving parity in teledentistry requires collaboration between health delivery systems, oral health stakeholders and policymakers to ensure that tele-dental services are accessible, affordable, and safe for all patients. Academic dentistry has an important role to play in leading this change and preparing the next generation of dentists to embrace and utilize tele-dental technology.
Teledentistry has the potential to optimize our dental practices, even in the post-pandemic period, by increasing access to dental care, improving patient outcomes, and reducing costs.
189. Mayo 2024 49 Teleodontología: un método para optimizar la atención dental
Calidad y dirección
Referencias
1. Islam MRR, Islam R, Ferdous S, Watanabe C, Yamauti M, Alam MK, Sano H. Teledentistry as an Effective Tool for the Communication Improvement between Dentists and Patients: An Overview. Healthcare (Basel). 2022 Aug 21;10(8):1586. doi: 10.3390/healthcare10081586. PMID: 36011243; PMCID: PMC9408418.
2. College of Dentistry, University of Florida, https://dental.ufl.edu/2020/07/06/teledentistry-helps-address-emergencies-during-covid-19/
3. Advancement of Teledentistry At The University of Rochester’s Eastman Institute For Oral Health. Dorota T. Kopycka-Kedzierawski, Sean W. McLaren & Ronald J. Billings. https://doi.org/10.1377/ hlthaff.2018.05102
4. Emami, E., Harnagea, H., Shrivastava, R. et al. Patient satisfaction with e-oral health care in rural and remote settings: a systematic review. Syst Rev 11, 234 (2022). https://doi.org/10.1186/ s13643-022-02103-2
5. Ignatius E, Perälä S, Mäkelä K. Use of videoconferencing for consultation in dental prosthetics and oral rehabilitation. J Telemed Telecare. 2010;16(8):467–70.
6. Herce J, Lozano R, Salazar CI, Rollon A, Mayorga F, Gallana S. Management of impacted third molars based on telemedicine: a pilot study. J Oral Maxillofac Surg. 2011;69(2):471–5.
7. Salazar-Fernandez CI, Herce J, Garcia-Palma A, Delgado J, Martín JF, Soto T. Telemedicine as an effective tool for the management of temporomandibular joint disorders. J Oral Maxillofac Surg. 2012;70(2):295–301.
8. Accuracy and effectiveness of teledentistry: A systematic review of systematic reviews. Nalia Gurgel-Juarez, Cassius Torres-Pereira, Ana E. Haddad) , 2022
9. da Silva HEC, Santos GNM, Leite AF, Mesquita CRM, de Souza Figueiredo PT, Dos Reis PED, Stefani CM, de Melo NS. The role of teledentistry in oral cancer patients during the COVID-19 pandemic: an integrative literature review. Support Care Cancer. 2021 Dec;29(12):7209-7223. doi: 10.1007/ s00520-021-06398-0. Epub 2021 Jul 5. PMID: 34219196; PMCID: PMC8255116.
10. Amtha R, Gunardi I, Astoeti TE, Roeslan MO. Satisfaction Level of the Oral Medicine Patients Using Teledentistry During the COVID-19 Pandemic: A Factor Analysis. J Int Soc Prev Community Dent. 2021 Jul 30;11(4):414-420. doi: 10.4103/jispcd.JISPCD_72_21. PMID: 34430503; PMCID: PMC8352063.
11. Rahman N, Nathwani S, Kandiah T. Teledentistry from a patient perspective during the coronavirus pandemic. Br Dent J. 2020 Aug 14:1–4. doi: 10.1038/s41415-020-1919-6. Epub ahead of print. PMID: 32801323; PMCID: PMC7427495.
Dentista y Paciente 50
12. Alabdullah JH, Daniel SJ. A Systematic Review on the Validity of Teledentistry. Telemed J E Health. 2018 Aug;24(8):639-648. doi: 10.1089/tmj.2017.0132. Epub 2018 Jan 5. PMID: 29303678.
13. Fernández CE, Maturana CA, Coloma SI, Carrasco-Labra A, Giacaman RA. Teledentistry and mHealth for Promotion and Prevention of Oral Health: A Systematic Review and Meta-analysis. J Dent Res. 2021 Aug;100(9):914-927. doi: 10.1177/00220345211003828. Epub 2021 Mar 26. PMID: 33769123.
14. https://adea.org/Press/Oct2021-Full-Promise-of-Teledentistry-Hinges-on-Dental-Education/
15. Kui A, Popescu C, Labune ț A, Alm ăș an O, Petru ț iu A, Pă curar M, Buduru S. Is Teledentistry a Method for Optimizing Dental Practice, even in the Post-Pandemic Period? An Integrative Review. Int J Environ Res Public Health. 2022 Jun 22;19(13):7609. doi: 10.3390/ijerph19137609. PMID: 35805267; PMCID: PMC9265299.
16. Lin GSS, Koh SH, Ter KZ, Lim CW, Sultana S, Tan WW. Awareness, Knowledge, Attitude, and Practice of Teledentistry among Dental Practitioners during COVID-19: A Systematic Review and Meta-Analysis. Medicina (Kaunas). 2022 Jan 15;58(1):130. doi: 10.3390/medicina58010130. PMID: 35056438; PMCID: PMC8781277.
17. Hung M, Lipsky MS, Phuatrakoon TN, Nguyen M, Licari FW, Unni EJ. Teledentistry Implementation During the COVID-19 Pandemic: Scoping Review. Interact J Med Res. 2022 Jul 21;11(2):e39955. doi: 10.2196/39955. PMID: 35862174; PMCID: PMC9307266.
18. Plaza-Ruíz SP, Barbosa-Liz DM, Agudelo-Suárez AA. Impact of COVID-19 on the Knowledge and Attitudes of Dentists toward Teledentistry. JDR Clin Trans Res. 2021 Jul;6(3):268-278. doi: 10.1177/2380084421998632. Epub 2021 Feb 25. PMID: 33632011.
19. Gurgel-Juarez, N., Torres-Pereira, C., Haddad, A. et al. Accuracy and effectiveness of teledentistry: a systematic review of systematic reviews. Evid Based Dent (2022). https://doi.org/10.1038/ s41432-022-0257-8
20. Olivier, Roy & Thibault, Dodin & Stéphane, Venuat & Aline, Dagregorio & Inquimbert, Camille & Jean, Valcarcel & Giraudeau, Nicolas. (2019). Oral Care in facilities for disabled people: interest of teledentistry. Dental, Oral and Maxillofacial Research. 5. 1-4. 10.15761/DOMR.1000303.
21. https://hpi.georgetown.edu/oralhealth/
22. Aquilanti, L.; Santarelli, A.; Mascitti, M.; Procaccini, M.; Rappelli, G. Dental Care Access and the Elderly: What Is the Role of Teledentistry? A Systematic Review. Int. J. Environ. Res. Public Health 2020, 17, 9053. https://doi.org/10.3390/ijerph17239053
189. Mayo 2024 51 Teleodontología: un método para optimizar la atención dental

Tratamiento ortodóncico
en paciente adulto tratado con extracciones de primeros molares permanentes. Reporte de caso
Dentista y Paciente 52 Sonriendo al futuro
Fotoarte: Editorial Renascence |
Fotografía: AdobeStock



Extraer los primeros molares permanentes puede ser una opción de tratamiento en ciertos casos de ortodoncia, como aquellos con apiñamiento moderado, biprotrusión, mordidas abiertas, o problemas de clase II y III que requieran extracciones. Además, se considera esta opción cuando los primeros molares están afectados por caries extensas u otras afecciones, lo que los hace más adecuados para la extracción y evita tratamientos restaurativos extensos o la necesidad de implantes en el futuro. Este artículo presenta el caso de una paciente en el que se optó por extraer los primeros molares superiores e inferiores para lograr resultados clínicos óptimos tanto en términos faciales como oclusales.
Palabras clave: extracción, primer molar, maloclusion, tratamiento ortodoncia.
Las extracciones dentales en los tratamientos de ortodoncia pueden ser indicadas en casos de caries extensas, restauraciones deficientes y/o extensas en premolares sanos, patologías periapicales, apiñamiento posterior y mordidas abiertas anteriores. La extracción de primeros molares permanentes es uno de los muchos planes de tratamiento en algunos casos de ortodoncia, en los cuales se presentan situaciones donde los primeros molares se encuentran comprometidos por lesiones cariosas extensas o alteraciones del desarrollo, por lo cual pueden ser candidatos para ser extraídos en casos donde se realizará tratamiento ortodóntico de pacientes como en los que se presentan apiñamiento moderado, biprotrusión, mordidas abiertas, clase II y III, casos en los cuales es necesario realizar exodoncias. Las extracciones posteriores producen una rotación antihoraria mandibular lo que podría ser conveniente en pacientes cuyas características faciales no se deben comprometer, como en pacientes con ángulo nasolabial obtuso, donde una significativa retracción de los dientes anteriores podría causar mayor apertura de este, lo que representaría en un resultado estético negativo y en camuflaje de pacientes clase II esqueléticas (extracciones superiores) y III (extracciones inferiores).1
189. Mayo 2024 53 Tratamiento ortodóncico
Cerrillo Lara Daniel. Ibarra Ramiro Jaime Tadeo. José de Jesús Anaya. Universidad Autónoma de Baja California. Campus Tijuana. Especialidad en Ortodoncia


Reporte del caso



Paciente del sexo femenino de 39 años de edad, sin datos patológicos aparentes, acude a la clínica de ortodoncia de la Facultad de Odontología campus Tijuana en diciembre del 2016. Su motivo de consulta fue: "Tengo el diente de abajo mal acomodado" En las fotografías extraorales se observa un paciente mesomorfo, biotipo mesoprosopo, línea superciliar asimétrica, línea bipupilar simétrica, nariz asimétrica, línea comisural asimétrica, labios medianos, tercio inferior aumentado respecto al medio y superior. Presenta perfil convexo, con un ángulo nasolabial obtuso (100°), surco mentolabial (122°). Línea dental superior desviada hacia la izquierda con respecto a línea media facial, muestra 100% de coronas dentales al sonreír. En el análisis intraoral se observa dentición permanente, líneas medias no coincidentes, microfracturas de OD #11 Y #21, clase molar indeterminada bilateralmente por ausencia de OD #16 Y #26, clase I canina bilateral, forma de arcada ovoide en superior, apiñamiento leve, #11, #12, #21 mesiorotados y #25 distorotado, forma de arcada ovoide en inferior, apiñamiento leve y OD #41 lingualizado, presencia de torus mandibular. Sobremordida horizontal de 2 mm y vertical de 20%. En el análisis radiográfico se muestran 26 dientes presentes en boca, ausencia de OD #16 y #26, presencia de #18, #28, #38 y #48 retenidos, altura de ramas mandibulares simétricas, densidad ósea

uniforme, relación corona-raíz 1:1; se observa además una maloclusión clase II esquelética, con crecimiento vertical, dientes anteroinferiores proinclinados así como los anterosuperiores.
Objetivos del tratamiento
Mejorar perfil del paciente, lograr clase molar I bilateralmente con mesialización de #37 y #47, después de extraer primeros molares mandibulares, mantener clase I canina bilateralmente, así como las sobremordidas vertical y horizontal, eliminar apiñamiento, corregir líneas medias, obtener oclusión funcional.
Plan de tratamiento interdisciplinario
Se remite al área de cirugía de la facultad de Odontología para extracciones de los OD #36 y #46 con el fin de armonizar la arcada inferior con la arcada superior, para después proceder a la mesialización de OD #37 y #47.
Plan de tratamiento ortodóncico
Se colocó aparatología fija superior e inferior tipo Alexander slot 0.022, se prosiguió a la alineación y nivelación, expansión superior e inferior con secuencias de arcos, mesialización de OD #37 y #47, recontorneo interproximal inferior, torque de raíces, armonización de arcadas, extracción de terceros molares inferiores y valoración de los superiores, retención removible superior e inferior.

Dentista y Paciente 54 Sonriendo al futuro
Figura 1. Fotografías extraorales de frente y de perfil.
Figura 2. Fotografías intraorales iniciales.







Resultados
Se obtuvieron los resultados mencionados al inicio como clase I molar y canina, sobremordidas adecuadas, eliminación del apiñamiento, corrección de líneas medias y una oclusión funcional.
Discusión
La prevalencia de las extracciones dentales en los tratamientos de ortodoncia ha variado a lo largo de los años y esto es corroborado por 40 años de estudios retrospectivos llevados por Proffit, quien demuestra que durante los años 50 el porcentaje de

extracciones aumentó en un 10%, en los 60 en un 50 % y para los años 80 observó una reducción del 35%, al igual que para Peck y Peck que fue del 32% en ambos arcos.2-3
La extracción de algún diente siempre ha sido tema de discusión y aún más cuando son extracciones de primeros molares, ya que en un tratamiento por lo regular se considera que estos órganos dentarios son llaves fundamentales de la oclusión; sin embargo, Pérez en 2015 afirma que el tratamiento con extracciones de primeros molares tiene resultados positivos en el perfil, tal como




189. Mayo 2����2�� 55 Tratamiento ortodóncico
Figura 3. Modelos de estudio iniciales.
Figura 4. Ortopantomografia inicial. Figura 5.
Figura 6. Fase de alineación y nivelación.



sucedió en este caso y los reportados por Bahoquez en 2015. Rey en 2012 menciona también aquí resultados favorables al extraer los primeros 4 primeros molares a pesar de ser considerados piezas claves en la oclusión.4-5
Conclusión
La extracción de los primeros molares se presenta como una alternativa







efectiva para abordar casos de mordida abierta esquelética, perfiles convexos, rotación horaria de mandíbula entre otros, logrando resultados estables, funcionales y estéticamente satisfactorios. Es crucial destacar que esta decisión terapéutica requiere una cuidadosa elección de casos, así como una habilidad clínica y experiencia considerable para asegurar que las expectativas y resultados del tratamiento no se vean comprometidos.6



Dentista y Paciente 56 Sonriendo al futuro
Figura 7. Cierre de espacios superior e inferior.
Figura 8. Retracción del segmento anterior.
Figura 9. Fotografias intraorales finales.





Referencias
1. Rey D, Oberti G, Sierra A. Extraccion del primer molar permanente como una alternativa en el tratamiento de ortodoncia. Rev. CES Odont. 2012;25(1) 44-53.
2. Proffit WR. Forty-year review of extraction frequencies at a university orthodontic clinic. Angle Orthod. 1994;64(6):407–14.
3. Peck S, Peck H. Frequency of tooth extraction in orthodontic treatment. Am J Orthod. 1979 nov;76(5):491–6.
4. G. (2015). Tratamiento de mordida abierta con extracciones de primeros molares. Reporte de caso. Revista Mexicana de Ortodoncia, 3(4), 266–273.
5. Bahoquez, A. (2015). Exodoncias de primeros molares y verticalización de tercer molar inferior en paciente con mordida abierta, reporte de caso. Revista Latinoamericana de Ortodoncia y Odontopediatria.
6. Seddon JL. Extraction of four first molars: a case for a general practitioner? J Orthod. 2004 jun; 31(2):80-5.
7. Daugaard-Jensen I. Extraction of first molars in discrepancy cases. Am J Orthod. 1973 ago;64(2):115– 36.
8. Williams R. Single arch extraction--upper first molars or what to do when nonextraction treatment fails. Am J Orthod. 1979 oct;76(4):376–93.
189. Mayo 2����2�� 57 Tratamiento ortodóncico
Figura 10. Fotografias intraorales finales. Figura 11. Radiografía lateral de cráneo final. Figura 12. Fotografias extraorales finales.

Mucho cuidado con los equipos de rayos X intraorales portátiles
¿Está justificada esta advertencia?
Dentista y Paciente 58 Boletín

La redacción
En Dentista y Paciente queremos que los odontólogos conozcan el riesgo que implica el uso indebido de fuentes de radiación ionizante.
Los equipos portátiles están diseñados para llevar a cabo una exposición con el operador sujetando el equipo con ambas manos, y debido a la imposibilidad de alejarse del mismo a la distancia reglamentada, el operador se encontrará expuesto a una dosis de radiación ionizante once veces mayor, siendo esto el mejor de los casos.
Estamos conscientes de que la mayoría de los odontólogos ignoran los riesgos que implica el uso de fuentes de radiación, los cuales aumentan con la frecuencia y dosis de la misma, es por eso que nuestro deber nos llama a advertir al odontólogo para prevenir antes que lamentar.
En la literatura sobre la seguridad radiológica con equipos intraorales portátiles, hemos observado un creciente número de opiniones negativas sobre el uso de equipos diseñados para que el operador los sujete con sus manos para poder llevar a cabo así, una toma radiográfica periapical.
Esto implica que, de utilizarse el equipo portátil en el consultorio dental, el odontólogo tendrá en sus manos la fuente generadora de radiación, algo

189. Mayo 2024 59 Mucho cuidado con los equipos de rayos X intraorales portátiles
que no estaba previsto en la Norma Reguladora de Seguridad Radiológica NOM-229-SSA1-2002 (https:// www.gob.mx/cms/uploads/attachment/file/839898/IB_NOM229_ Infografia_24-03-2023_light.pdf), misma que excluyó de su campo de aplicación los equipos de rayos X convencionales, por considerar que los equipos de rayos X periapicales fijos tradicionales no presentarían mayores riesgos sanitarios al ser utilizados con los protocolos de seguridad sugeridos por ALARA, ICRP y otras instituciones, mismas que recomiendan mantener una distancia mínima de 2 metros entre el operador y la fuente generadora de rayos X, al efectuar el disparo mediante un disparador con cable retráctil, o con la opción de instalar un disparador remoto fuera del cuarto radiográfico.

Muchos odontólogos ignoran o subestiman los daños de tipo determinísticos o estocásticos, que son los causantes de provocar alteraciones cromosómicas a la célula, esto debido al uso indebido de fuentes


Muchos odontólogos ignoran o subestiman los daños de tipo determinísticos o estocásticos, que son los causantes de provocar alteraciones cromosómicas a la célula, esto debido al uso indebido de fuentes generadoras de radiación ionizante, pues aquellos que no lo saben suelen considerar al equipo portátil un avance tecnológico, cuando en realidad estos productos fueron diseñados para otras aplicaciones, al considerar que en sus países de origen su uso en el consultorio dental está restringido por normas de seguridad radiológica, debido a la imposibilidad para el operador de alejarse de la fuente de radiación, exponiéndose así a una dosis de radiación ionizante, por radiación dispersa y de fuga, mucho mayor de la que recibiría con un equipo fijo tradicional, al aplicar los protocolos antes mencionados.

Dentista y Paciente 60 Boletín




















En la literatura sobre la seguridad radiológica con equipos intraorales portátiles, hemos observado un creciente número de opiniones negativas sobre el uso de equipos diseñados para que el operador los sujete con sus manos para poder llevar a cabo así, una toma radiográ����ca periapical��



Referencias
1. RAGGI X IN MEDICINA-FISICA- TECNICA-APPLICAZIONI. Ed. GILARDONI S.p.A. 2.1.4.
2. ODOVTOS – Actualización en equipos de Rayos X portátiles en odontología. Lucía Barba Ramírez DDS, Deivi Cascante Sequeira DDS. Publicado en línea : 15-II-2021. Recuperado de: https://www.scielo.sa.cr/pdf/odovtos/v24n2/2215-3411-odovtos- 24-02-26.pdf
3. Revisión de las principales normas de protección radiológica para el uso de equipos de Rayos-X en odontología. Recuperado de: https://revistas.cientifica.edu.pe/index.php/ odontologica/article/download/538/6 19/
4. Guidance for Industry and FDA Staff: Radiation Safety Considerations for X-RAY Equipments Designed for Hand-Held Use. U.S. Department of Health and Human Services. Center for Devices and Radiological Health (CDRH). Recuperado de: https://www.fda. gov/media/73890/download
5. Justification and good practice in using handled portable dental X-RAY equipments. Academy of Dentomaxilofacial Radiology (EADMFR), (2015) 44, 20140343. Published by the British Institute of Radiology. Recuperado de: https://www.ncbi.nlm.nih.gov/ pmc/articles/PMC4628399/pdf/dmfr.20140343.pdf
189. Mayo 2����2�� 61 Mucho cuidado con los equipos de rayos X intraorales portátiles

Dentista y Paciente 62
Estudio
Fotoarte: Editorial Renascence | Fotografía: AdobeStock
¿Bloque óseo autólogo o xenogénico para ensanchar la cresta alveolar?
Autores:
Giuseppe Alexandre Romito, Marcelo
Augusto Fonseca, Herbert Horiuti Soares, Rafael de Oliveira Lazarin, Vitor Marques
Sapata, Roger Nishyama, Marina Clemente
Conde, Christoph Hammerle, Frank Schwarz, Cristina Cunha Villar.
Relatores:
Rocío Bujaldón e Ignacio Zúñiga, supervisado por Prof. David Herrera y Prof. Mariano Sanz.
Traducción:
Borja Rodríguez. Alumno del Máster de Periodoncia, Universidad de Santiago de Compostela, A Coruña.
Afiliación:
Programa de posgrado en periodoncia, Universidad Complutense, Madrid.
Antecedentes
Después de una extracción dental cambian las dimensiones del hueso, tanto en las crestas alveolares anteriores como posteriores. La región anterior del maxilar y su hueso vestibular son la parte más vulnerable involucrada en este proceso.
Dado que estos cambios dimensionales pueden afectar de forma negativa a la colocación del implante y a la planificación del tratamiento, a menudo se requieren procedimientos de injerto óseo previos o simultáneos a la colocación de implantes guiados protésicamente.
Cuando resulta difícil conseguir la estabilidad primaria del implante
simultáneamente al aumento de cresta, y en crestas edéntulas severamente atróficas con defectos óseos no contenidos, se propone un procedimiento de aumento óseo por etapas.
Aunque los bloques óseos autólogos (ABB) se consideran el material de injerto más fiable y exitoso, presentan ciertas limitaciones, como una alta morbilidad y una baja disponibilidad intraoral. Para intentar superar estas desventajas se han propuesto materiales alternativos para injertos óseos.
Entre ellos, el bloque óseo xenogénico colagenado equino (CXBB) ha mostrado buenos resultados en estudios preclínicos y clínicos, y no ha mostrado ser inferior al ABB. Sin
embargo, los datos longitudinales que comparan los resultados clínicos de implantes colocados en crestas aumentadas utilizando ABB o CXBB son escasos y ofrecen una fiabilidad limitada.
Objetivo
El propósito principal de este estudio fue evaluar la tasa de supervivencia de implantes colocados en crestas alveolares previamente aumentadas con ABB o CXBB después de 12 meses de seguimiento.
Materiales y métodos
• Este estudio no intervencionista de un solo centro incluyó a 64 pacientes que se sometieron a un
189. Mayo 2024 63
¿Bloque óseo autólogo o xenogénico para ensanchar la cresta alveolar?
aumento óseo lateral realizado con ABB o CXBB antes de la colocación del implante. Los pacientes fueron reclutados de un ensayo clínico aleatorizado (RCT) previo realizado por el mismo grupo de investigación.
• Los pacientes recibieron la colocación del implante y la restauración final atornillada a las 30 semanas (ABB) y a las 41 semanas (CXBB) después del procedimiento de aumento óseo. Durante la colocación del implante, cuando fue necesario se realizó una regeneración ósea guiada con hueso bovino desproteinizado (DBBM) y membrana de colágeno (CM). Todos los implantes cicatrizaron de forma sumergida. Los pacientes fueron incluidos en un programa de mantenimiento periodontal según sus necesidades individuales.
• El objetivo principal fue la supervivencia del implante, definida como la presencia del implante en la boca del paciente durante el periodo de seguimiento de un año. Como objetivo secundario se evaluó el éxito del implante. La visita de seguimiento estaba programada a los 12 meses, pero se realizó

El objetivo de esta investigación es establecer los factores predisponentes que in������������n����n�������������������������������� del tratamiento tras la in������v��nción q��i��ú��gic���� de los defectos p����iimp����n������i����, c��n������ sin injerto de sustitución ósea.
de inserción. El tejido queratinizado (KT) se midió en la localización medio-bucal.
• La estética del tejido blando alrededor de los implantes se evaluó según el índice estético rosa (PES). Se tomaron impresiones ópticas en 2 momentos del estudio (después de colocar la corona y en la visita de seguimiento a un año) para estimar el grosor del tejido blando y, con esta información, se evaluaron los cambios en el perfil del tejido.
• Se evaluaron las medidas de resultado informadas por el paciente (PROMs), que incluyeron la incomodidad posoperatoria y la satisfacción general, con una escala visual analógica.
Resultados
• Se analizaron un total de 50 implantes, 28 pacientes del grupo CXBB y 22 del grupo ABB.
• Se produjeron fracasos tempranos antes de la conexión del aditamento (6 en el grupo CXBB y dos en el grupo ABB) y no se produjeron fracasos tardíos en ninguno de los grupos.
22.6 meses después de la

• índice de placa modificaperiimplantario y nivel
14.9 meses después de la colocación de la restauración y 22.6 meses después de la colocación del implante debido a la pandemia global de COVID-19. Los parámetros clínicos fueron registrados por un único investigador calibrado con una sonda periodontal en 6 sitios por implante: índice de placa modificado, sangrado al sondaje (BOP), profundidad de sondaje (PD), posición del margen mucoso periimplantario y nivel
• Las tasas de supervivencia y éxito del implante fueron del 78.6% y 53.6% respectivamente para el grupo CXBB, y del 90.9% y 63.6% respectivamente para el grupo ABB. Las diferencias entre los grupos no fueron estadísticamente significativas.
• No se observaron diferencias estadísticamente significativas en los parámetros clínicos entre los dos grupos. Ambos grupos mostraron aproximadamente un 50% de BOP sin un incremento en la PD. La única variable que presentó una mayor diferencia fue el KT, pero sin diferencias significativas entre los grupos.
Dentista y Paciente 64 Estudio
Figura: representación esquemática de las líneas de referencia utilizadas para evaluar los cambios en el grosor del tejido
eTT 5 mm
eTT 3 mm
eTT 1 mm
PI-MM basal

Contorno basal - colocación de la corona
Grosor estimado de tejido en basal
Contorno a un año de seguimiento
Grosor estimado de tejido a un año de seguimiento
Línea vertical de referencia
Líneas horizontales de referencia

Nota: Se utilizaron imágenes transversales centrales del sitio objetivo para establecer una línea vertical de referencia (línea blanca) paralela al eje del implante. En el registro basal, se posicionó una línea horizontal (PI-MM) a nivel del margen mucoso periimplantario. Posteriormente, se colocaron tres líneas horizontales adicionales a 1, 3, y 5 mm apicales a la línea de referencia PI-MM. Para evaluar el grosor del tejido (eTT) y los cambios en el eTT, se midió la distancia entre la línea vertical de referencia y el contorno del tejido blando vestibular a 1, 3, y 5 mm por debajo del margen mucoso periimplantario para cada punto temporal.
Resultados
Figura: representación esquemática de las líneas de referencia utilizadas para evaluar los cambios en el grosor del tejido. Nota: Se utilizaron imágenes transversales centrales del sitio objetivo para establecer una línea vertical de referencia (línea blanca) paralela al eje del implante. En el registro basal, se posicionó una línea horizontal (PI-MM) a nivel del margen mucoso periimplantario. Posteriormente, se colocaron 3 líneas horizontales adicionales a 1, 3, y 5 mm apicales a la línea de referencia PI-MM. Para evaluar el grosor del tejido (eTT) y los cambios en el eTT, se midió la distancia entre la línea vertical de referencia y el contorno del tejido blando vestibular a 1, 3, y 5 mm por debajo del margen mucoso periimplantario para cada punto temporal.
• Se analizaron un total de 50 implantes, 28 pacientes del grupo CXBB y 22 del grupo ABB.
• Se produjeron fracasos tempranos antes de la conexión del aditamento (seis en el grupo CXBB y dos en el grupo ABB) y no se produjeron fracasos tardíos en ninguno de los grupos.
en ambos grupos: 85.6 en CXBB, y 88.5 en ABB.
• El valor de PES fue ligeramente mayor, pero no estadísticamente significativo, en el grupo ABB (10,4) en comparación con el grupo CXBB (8,8). El color y la textura del tejido blando recibieron las puntuaciones más altas, mientras que las puntuaciones más bajas se atribuyeron a la papila y al proceso alveolar.
Limitaciones
• Las tasas de supervivencia y éxito del implante fueron del 78,6% y 53,6% respectivamente para el grupo CXBB, y del 90,9% y 63,6% respectivamente para el grupo ABB. Las diferencias entre los grupos no fueron estadísticamente significativas.
• No se observaron diferencias estadísticamente significativas en los parámetros clínicos entre los dos grupos. Ambos grupos mostraron aproximadamente un 50% de BOP sin un incremento en la PD. La única variable que presentó una mayor diferencia fue el KT, pero sin diferencias significativas entre los grupos.
• El valor de PES fue ligeramente mayor, pero no estadísticamente significativo, en el grupo ABB (10.4) en comparación con el grupo CXBB (8.8). El color y la textura del tejido blando recibieron las puntuaciones más altas, mientras que las puntuaciones más bajas se atribuyeron a la papila y al proceso alveolar.
Limitaciones
• El grupo CXBB experimentó un incremento medio general en el grosor del tejido blando de 0.2 mm y el grupo ABB de 0.2 mm, con una respectiva ganancia volumétrica media de 11.3 mm² y 12.5 mm².
• El grupo CXBB experimentó un incremento medio general en el grosor del tejido blando de 0,2 mm y el grupo ABB de 0,2 mm, con una respectiva ganancia volumétrica media de 11,3 mm² y 12,5 mm².
• La ausencia de diferencias estadísticamente significativas podría explicarse por el tamaño reducido de la muestra.
• En cuanto a las PROMs, el cuestionario OHIP-14 fue ligeramente favorable en el grupo ABB, principalmente en las variables de malestar psicológico e incapacidad. Las puntuaciones de satisfacción general fueron similares en ambos grupos: 85,6 en CXBB, y 88,5 en ABB.
• La ausencia de diferencias estadísticamente significativas podría explicarse por el tamaño reducido de la muestra.
• No hay datos clínicos disponibles sobre los pacientes que no fueron incluidos en el seguimiento del estudio. Por lo tanto, puede existir un sesgo de selección.
• No hay datos clínicos disponibles sobre los pacientes que no fueron incluidos en el seguimiento del estudio. Por lo tanto, puede existir un sesgo de selección.
• En cuanto a las PROMs, el cuestionario OHIP-14 fue ligeramente favorable en el grupo ABB, principalmente en las variables de malestar psicológico e incapacidad. Las puntuaciones de satisfacción general fueron similares
• La validez externa resulta limitada porque todos los procedimientos quirúrgicos fueron realizados por un único clínico. Además, ninguno de los casos incluidos presentaba defectos horizontales extensos, por lo cual los resultados de este estudio no pueden extrapolarse a casos graves.
Conclusiones e impacto
• El aumento óseo lateral por etapas en crestas alveolares atróficas, ya sea mediante bloques óseos autólogos o xenogénicos equinos, logra tasas excepcionales de supervivencia y éxito en implantes dentales.
• La validez externa resulta limitada porque todos los procedimientos quirúrgicos fueron realizados por un único clínico. Además, ninguno de los casos incluidos presentaba defectos horizontales extensos, por lo cual los resultados de este estudio no pueden extrapolarse a casos graves.
• Ambos grupos obtuvieron elevadas tasas de satisfacción de los pacientes, resultados estéticos satisfactorios y condiciones periimplantarias estables.
• El injerto en bloque óseo xenogénico colagenado (CXBB) puede considerarse como una alternativa clínica viable al uso del injerto en bloque autólogo (ABB) en áreas de aumento de la cresta alveolar, reduciendo la morbilidad de los pacientes. Se debe realizar una cuidadosa selección de los casos.
JCP Digest 121 es un resumen del artículo “Clinical outcomes following atrophic alveolar ridge reconstruction using collagenated xenogeneic bone block or autogenous bone block: One-year follow-up of a randomized controlled clinical” J Clin Periodontol. 51 (01):14-23. DOI: 10.1111/jcpe13891.
https://www.onlinelibrary.wiley.com/doi/10.1111/jcpe.13891 Acceso a través de la página web para miembros de la EFP http://efp.org/members/jcp.php
Con el amable permiso de Wiley Online Library. Copyright © 1999-2024 John Wiley & Sons, Inc. Todos los derechos reservados. JCP Digest es una publicación de la Federación Europea de Periodoncia (EFP). Oficina EFP: Cink Coworking, oficina 17, calle Henri Dunant 15-17, 28036 Madrid, España · www.efp.org
189. Mayo 2����2�� 65 ¿Bloque óseo autólogo o xenogénico para ensanchar la cresta alveolar?
Conclusiones e impacto
• El aumento óseo lateral por etapas en crestas alveolares atróficas, ya sea mediante bloques óseos autólogos o xenogénicos equinos, logra tasas excepcionales de supervivencia y éxito en implantes dentales.
• Ambos grupos obtuvieron elevadas tasas de satisfacción de los pacientes, resultados estéticos
satisfactorios y condiciones periimplantarias estables.
• El injerto en bloque óseo xenogénico colagenado (CXBB) puede considerarse como una alternativa clínica viable al uso del injerto en bloque autólogo (ABB) en áreas de aumento de la cresta alveolar, reduciendo la morbilidad de los pacientes. Se debe realizar una cuidadosa selección de los casos.
Notas
JCP Digest 121 es un resumen del artículo “Clinical outcomes following atrophic alveolar ridge reconstruction using collagenated xenogeneic bone block or autogenous bone block: One-year follow-up of a randomized controlled clinical” J Clin Periodontol. 51 (01):14-23. DOI: 10.1111/jcpe13891.
https://www.onlinelibrary.wiley.com/doi/10.1111/jcpe.13891
Acceso a través de la página web para miembros de la EFP http://efp.org/members/jcp.php
Con el amable permiso de Wiley Online Library. Copyright © 1999-2024 John Wiley & Sons, Inc. Todos los derechos reservados. JCP Digest es una publicación de la Federación Europea de Periodoncia (EFP). Oficina EFP: Cink Coworking, oficina 17, calle Henri Dunant 15-17, 28036 Madrid, España · www.efp.org
Dentista y Paciente 66 Estudio